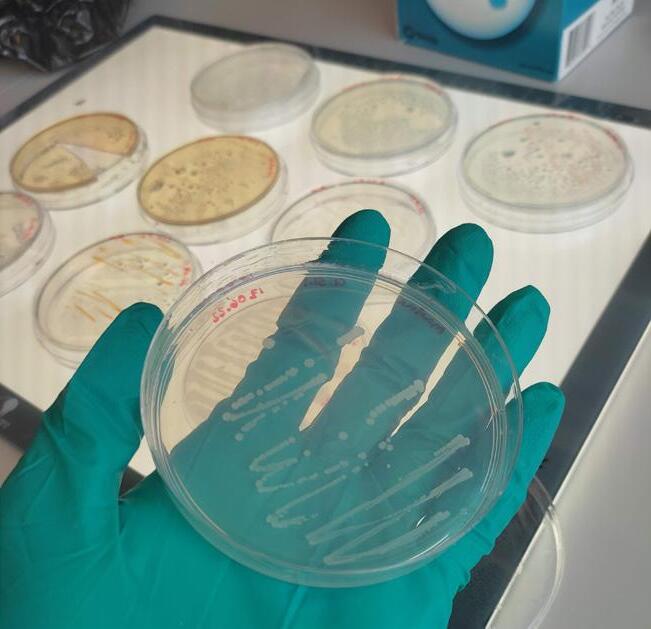

TEMA:
Hallå där
Per Pettersson
sid 4
Framtidens mat tar form
Från oönskad bifångst till krispig fish cake
sid 8


TEMA:
Hallå där
Per Pettersson
sid 4
Framtidens mat tar form
Från oönskad bifångst till krispig fish cake
sid 8

Nu är våren här med ljusa morgnar, ljumma temperaturer och vi har fått en försmak av vårens allra första primörer. Redan i slutet på mars var det dags för årets tångpremiär. Tunna, spröda sockertångsplantor och havssallatsblad samsades på årets premiär. Läs mer om tångpremiären på sidan
4. Men den riktiga våren inträffar först när makrillen kommer och kanske är så fallet när du sitter med tidningen i handen.
Här är årets andra utgåva av Svensk Fisknäring med tema: produktutveckling. Matförsörjningsförmågan i landet behöver bli starkare och vägarna dit är många. På sidan 8-9 får vi en inblick i hur arbetet fungerar som produktutvecklare. Anna Henning Moberg och Veronica Öhrvik på Axfoundation jobbar med hela värdekedjan från båt till bord för att lyfta braxen, från bifångst till matfisk. En resa som inneburit många utmaningar och som krävt kreativa lösningar. Inte minst har man fått arbeta med mångas förutfattade meningar, om att braxen är en skräpfisk.
Vi fortsätter också följa Blå Mats unga forskare på sidan 10-11. Turen har kommit till Evangelia Zioga som forskar på fermentering av alger. Här handlar det inte om fermentering som konserveringsmetod utan om produktutveckling. Hur man kan nyttja fermentering för att få fram specifika smaker?
Ny teknisk innovation kan handla om att gräva där man står, att bättre ta tillvara resurser som redan finns. Bra exempel på det är de projekt som bedrivs i Ellös, där forskare och entreprenörer hjälps åt för att hitta nya produkter. Här finns bra exempel med både sill och blåmussla som ni kan läsa mer om på sidorna 12-13.
Livsmedel och livsmedelsproduktion har efter en orolig och omskakande tid hamnat i ett helt nytt fokus. I en period som präglats av hög inflation, prishöjningar, höjda ränte- och energikostnader och skenande livsmedelspriser så behövs nytänkande. Frågan om vad som blir den blå näringens falukorv ställer sig både Blå mat och Fiskbranschens riksförbund. Läs deras tankar i respektive spalt på sidan 15 och sidan 25.
Vad som är eller blir den blå näringens falukorv är också något vi
fördjupar oss i nästa nummer av tidningen som har tema: processade livsmedel.
Till sist önskar vi er läsare en fin vår!
Linda Frithiof, Sjömatsfrämjandet
Vill du ha vårt digitala nyhetsbrev?
Som ett komplement till Svensk Fisknäring i pappersformat finns nu ett digitalt nyhetsbrev som kommer ut mellan tidningsutgivningarna.
Vill du ha tillgång till det kan du scanna QR koden med din mobil, och fylla i dina uppgifter, eller kontakta oss så hjälper vi dig.
HaV = Havs- och vattenmyndigheten www.havochvatten.se
ICES = Internationella havsforskningsrådet
FAO = FNs livsmedels- och jordbruksorganisation www.fao.org
MSC = Marine Stewardship Council, en miljöcertifiering för hållbart fiske. www.msc.org
RISE = Research Institutes of Sweden www.ri.se
SLU = Sveriges lantbruksuniveritet. www.slu.se
Slv = Svenska livsmedelsverket www.slv.se
WWF = Världsnaturfonden www.wwf.se
FR = Fiskbranschens Riksförbund www.fiskbranschen.se
GFA = Göteborgs Fiskauktion www.gfa.se
SFPO = Sveriges fiskares producentorganisaton www.sfpo.se
SPF PO = Swedish Pelagic Federation PO. www.pelagic.se
HKPO = Havs- och Kustfiskarnas producentorganisation www.hkpo.se
SVC = Svenska Västkustfiskarnas Centralförbund
SIC = Svenska Insjöfiskarenas Centralförbund www.insjofiskare.se

SVoS = Svenskt Vattenbruk och Sjömat
Demersalt fiske = fiske som sker nära botten
Pelagiskt fiske = fiske som sker högre upp från botten
Vattenbruk = odling av fisk eller skaldjur
Landning = den fisk eller de skaldjur man tar iland
Lekbiomassa = den del av beståndet som uppnått könsmognad
MSY = Maximum sustainable yield (Maximalt uthålligt uttag)
TAC = Total allowable catch (Total fångstkvot av en art under ett år)
RAC = Regional advisory council
SVENSK FISKNÄRING
ADRESS Sjömatsfrämjandet, Fiskhamnsgatan 33, 414 58 Göteborg, 031-85 00 54. info@sjomatsframjandet.se
ANSVARIG UTGIVARE Roger Thilander 070-562 40 19 ANNONSER Roger Thilander 070-562 40 19 LAYOUT OCH TRYCK Lotta Bernhed, Billes Tryckeri AB, Mölndal. www.billes.se
OMSLAGSBILD Produktion på Öckerö hav. Foto: Martin Ries
Ladda ner vår app Kustväder till din iPhone eller Android. Här finns all väderdata och dessutom bilder på hur havet ser ut vid olika vindstyrkor och väderförhållanden.
Sid.
4 Tångpremiär 2023
4 Hallå där Per Pettersson
5 Vägen framåt mot mer livsmedel av svenskfångad sill och skarpsill
6 KOASTAL erbjuder fiskare ett extra ben att stå på
7 Skapar förutsättning för en växande vattenbruksnäring i Sverige
8 Framtidens mat tar form – Från oönskad bifångst till krispig fish cake



10 Blå mats unga forskare – Evangelia Zioga
12 Restresursfabriken

15 Från underutnyttjad art till premiumprodukt

16 En fiskare med smak för sött och salt
19 Testbädd för sjömatsproduktion med stor potential
22 Dryckestips – vårnyheter
25 Arter i säsong
30 Saxat & På gång
Förtydligande nr 1 2023 s.5
Magnus Andersson arbetar på Landsbygds- och infrastrukturdepartementet, före 1 januari 2023 Näringsdepartementet.
För tredje året i rad hölls tångpremiär sista torsdagen i mars. Nytt för i år var att utöver sockertång, såldes även havssallat. Premiärlådan som såldes var ett paket med tre lådor, en från respektive odlare, till förmån för Sjöräddningen.
På årets auktion hade tre tångbönder levererat tång. Ten Island Seafarm som varit initiativtagare till tångpremiären när den startade för två år sedan har jobbat hårt för att lyfta tången. Utöver Ten Island Seafarm lämnade även Kaira Nordic sockertång och Nordic Seafarm levererade havssallat. Premiärlådan som bestod av en låda från respektive odlare klubbades hem av Thomas Cruz Kollberg på Luckans fisk vid Mariaplan i Göteborg för 620 kr. Hela beloppet går oavkortat till Sjöräddningen.


Hej Per! Du är ny ombudsman på Svenska Insjöfiskarenas Centralförbund, SIC, sedan början av oktober 2022. Du sitter också med i Stockholms Viltförvaltningsdelegation samt Mälarens Vattenvårdsförbund.
Har du börjat komma in i din roll?
Jadå, det mesta är bekant. Mats Ingemarsson och Mats Eriksson är dessutom duktiga på att hjälpa och heja.
Vad har du för bakgrund?
Liksom Mats och Mats har jag en gård med jord- och skogsbruk. Pengarna har jag dock tjänat på att odla sallat och kryddor i kruka i växthus. Men jag sålde rörelsen för 10 år sedan. Sedan dess har jag producerat ekologisk näring men mest varit förtroendevald i LRF, nu som ordförande i LRF Mälardalen. Jag har avsagt mig uppdraget och avgår 15/3. Sen blir det fiske för hela slanten
Vad kommer du att ha för roll på SIC?
Jag är ombudsman. Men tanken är att jag skall ta över VD-skapet i SIC efter Mats Ingemarsson. Organisationen är inte så stor…

Vad jobbar du med just nu? Några spännande projekt?
Det är nog fler än jag som i och med regeringsskiftet tror på en förändring på HaV. Där måste vi vara med. Annars är det braxenfärs, alternativ användning av siklöjan, MSC, marknadsföring av svensk sötvattenkräfta och reduktionsfiske av stor sik i Vänern för att på det sättet få bort dioxin ur sjön.
Vad har du för relation till fisket?
Knappt någon. Men jag vet förstås att det är en urgammal bransch som åtnjuter ett närmast perverst politiskt intresse. Ungefär som lantbruket.
Om du själv får välja, vad äter du helst för sjömat?
Det beror på tillfället, idag när det yr snöflingor i blåsten så är en fisksoppa given, gärna med lake. Gädda är bra helgmat och till fest så är det aldrig fel med ostron och kräftor, havs- eller sötvatten. Godast är nog ändå räkor. Fast jag åt ovanlig sjömat igår, coq au vin på sångsvan.
Linda FrithiofVad händer med premiärlådan nu Thomas?
– Vi kommer sälja den i lösvikt i fiskdisken. Extra kul tycker vi det är med havssallaten. Den har det varit mycket snack om i år. Den har en lätt doft och smak av tryffel och smakerna binds lätt med hjälp av lite fett, därför är den lämplig i varma såser som till exempel en hollandaise.

Använder ni tången själva i några rätter?
– Vi brukar göra det. Nu ligger tångpremiären så nära påsk att vi nog inte hinner med det förrän efter, men vi brukar ha den i sillinläggningar och även i en del lunchrätter.
Linda FrithiofTesta Steeltechs industrigryta med tillhörande beredningsbänkar.
KOKA SKALDJUR/SOPPA/POTATISMOS
SNABB UPPVÄRMNING
FRAMTAGEN FÖR INDUSTRIN
LÄTTSKÖTT/ENKEL RENGÖRING
www.steeltech.se

I februari 2022 fick Jordbruksverket i uppdrag av regeringen att analysera svensk fiskberedning utifrån produktion och mottagningskapacitet samt att identifiera hinder och utvecklingsbehov för att en större andel av den svenskfångade fisken ska kunna landas och beredas i Sverige. Uppdraget genomfördes i dialog med näringen och beaktar såväl beredskapsperspektivet som sektorns betydelse för en växande bioekonomi. Rapporten släpptes den 31 mars och kan läsas i sin helhet på Jordbruksverkets hemsida.
Jordbruksverket har i dialog med Landsbygds- och infrastrukturdepartementet avgränsat studien till de två pelagiska arterna sill/strömming och skarpsill. Detta på grund av de stora volymerna som dessa arter utgör. Under 2021 stod sill för 50% och skarpsill för 33% av de totala svenska fångsternas volym. I rapporten konstateras att det redan idag skulle kunna landas betydligt större kvantiteter sill och skarpsill i svenska hamnar för livsmedelsproduktion än vad som är fallet. Rapporten presenterar hinder och åtgärder för att landningar till svensk beredningsindustri ska öka och därmed nå Livsmedelsstrategins målsättning om ökad livsmedelsproduktion. Chalmers tekniska högskola har bidragit till utredningen och presenterar en studie över potentialen i underutnyttjade restströmmar i svensk beredningsindustri.
Tillgång på fisk i form av välmående fiskbestånd är givetvis en grundförutsättning för att fångsten ska kunna landas och beredas i Sverige. Pelagiskt fiske har ett lågt klimatavtryck jämfört med många andra animaliska livsmedel. Sill och skarpsill innehåller dessutom ämnen som har en positiv effekt på hälsan. Den viktigaste faktorn för att stärka möjligheten att nyttja svenskfångad sill och skarpsill under en eventuell kris är att lossnings- och beredningskapacitet finns på plats och används även i icke-kristid.
Jordbruksverket belyser utmaningar och möjligheter
Rapporten belyser åtgärder och utvecklingspotential kopplat till olika funktioner i den blå värdekedjan och hur dessa fungerar med varandra. I rapporten tar man upp bland annat vilken kapacitet som svensk beredningsindustri har och vilka beredningsmöjligheter som finns. I relation till de svenska fiskemöjligheternas storlek (total
tillgänglig volym) skulle mer kunna beredas i Sverige. Rapporten belyser även behovet av att fortsätta arbetet med att studera nivåer av oönskade ämnen i fisk. Det finns också ett behov av att utveckla jämnare efterfrågan på sill och skarpsillsprodukter. Detta kan stödjas av att arbeta med att utveckla nya produkter och etablera nya exportmarknader. Jordbruksverket presenterar förändringsförslag på 16 punkter.

Förändringsbehov (ett urval) Rapporten innehåller en kartläggning över den pelagiska blå värdekedjan för sill och skarpsill. Den belyser vilka förändringsbehov som aktörerna har fört fram i diskussioner med Jordbruksverket. Några av dessa förändringsbehov är:
Bättre kompatibilitet mellan fiskefartyg, hamnar och beredningsindustri Fiskeflottan, hamnar och beredningsindustri har utvecklats i otakt. Vid investeringar och utveckling av den blå värdekedjan måste alla parter beakta varandras möjligheter och behov.
Justeringar av fiskeförvaltningen Fiskeförvaltningen behöver beakta såväl fiskets som beredningsindustrins behov, tillsammans med grundläggande målsättning om ekosystemens hållbarhet. Flera aktörer har fört fram vikten av att bevara en spridning av storleksstrukturen i bestånden. Flera aktörer efterfrågar också en ökad regional koppling till förvaltningen.

Utveckling i beredningsledet För att stärka efterfrågan och jämna ut den över året föreslårs att sektorn arbetar med att utveckla nya produkter, svenskmärkning, kommunikation av kostrekommendationer och etablera nya exportmarknader samt förvalta befintliga. Det krävs också bättre
samverkan mellan de olika leden i den blå värdekedjan för att åstadkomma detta.
Beredskap för olika typer av kriser och förändringar
Rapporten konstaterar att den bästa beredskapen för att hantera kriser och förändringar är att ha en robust värdekedja med tillräcklig lossnings- och beredningskapacitet för att kunna skala upp, eller ställa om, produktionen i en krissituation. Beredskap kan också innefatta förmåga att kunna ta hand om arter och restströmmar som normalt inte ingår i livsmedelsförsörjningen.
I sektorn finns kunskaperna om vad som behöver förändras. Om de olika aktörerna i den blå värdekedjan kan skapa ett fördjupat samarbete i alla riktningar så är det något som alla skulle vinna på. Därför konstaterar Jordbruksverket att om näringen själva kan få till stånd ökade landningar i Sverige så skulle detta ge störst flexibilitet och de bästa lösningarna för alla parter.
KOASTAL har en idé om att erbjuda en helhetslösning för den fiskare som vill utöka sin verksamhet med en tångodling. Samuel och August träffades genom en gemensam vän och kom bra överens. De delade samma passion och vilja att göra något positivt för havet och den svenska fiskeindustrin. Efter att ha startat upp ett samarbete med fiskaren Göran Larsson är de nu på väg in i ett utvecklingsskede.
Ni tar bland annat hand om hinder och gör tångodling till en effektivare och enklare process för odlaren.
– Ja i dag finns det en mängd hinder för någon som vill börja odla tång. En utdragen och komplicerad tillståndsprocess och stora ekonomiska satsningar gör det onödigt svårt och kostsamt att ta del av alla de möjligheter som tången kan skapa, säger August.
Odlaren får genom KOASTAL tillgång till all nödvändig utrustning, såplantor och utbildning för att kunna driva en effektiv och lönsam odling. De garanterar även ett återköp av all den tång som odlaren skördar och transporterar in till hamn, allt för att minska och effektivisera de kritiska momenten som många odlare känner är mest utmanande och som de kämpar mest med.
Berätta lite om er idé och vad det är ni kan hjälpa till med. – Vi erbjuder en helhetslösning som gör en odling mer lönsam på kortare tid. Att direkt kunna få igång sin odling och få lönsamhet redan första året är svårt om man väljer att starta en odling på egen hand. Men via oss så minskas arbetsmängden och behovet av att samla all information och hantera de olika momenten på egen hand. Odlaren kan fokusera sin tid på det praktiska i att sköta odlingen. Det gör också att man vet vilken arbetsmängd det innebär och att det inte kommer påverka ens andra verksamhet negativt. En eller flera odlingar kan fungera som ett bra komplement till alla typer av fisken och kan skapa en diversifiering och ökad inkomst.
Varför blev det just sockertång?
– Sockertång är den ledande arten både i Sverige och Europa, där den största marknaden också finns. Det är en väl beprövad art som lämpar sig mycket bra för att odla i våra vatten. Det finns projekt igång nu som testar möjligheterna att odla andra arter, såsom havssallat eller dulce, och ifall dessa fungerar lika bra som sockertången är det absolut något vi är intresserade av.
I dag har ni en odling i Bohuslän utanför Hunnebostrand. Hur startade det samarbetet?
– Det var när vi var i Hunnebostrand för att leta efter fiskare att samarbeta med som vi stötte på Göran Larsson och hans båt, LL94 Sofia. Hans namn kom ofta upp när vi frågade folk i byn och han, likt många andra i Hunnebostrand, var väldigt hjälpsamma och tyckte det lät som ett bra och spännande projekt. Samarbetet har varit viktigt både för att testa och lära oss hur ett samarbete mellan oss och en yrkesfiskare kan se ut men också för att lära oss själva mer om de olika momenten i att driva en odling och hur arbetet faktiskt ser ut. Göran har varit med i alla momenten av odlingens drift och

Samuel Amant är född i Belgien och har en kandidat i Biotechnical Engineering därifrån. 2021 flyttade han till Sverige för att studera till en master i Entreprenörskap vid Lunds universitet. I Lund fick han också möjlighet att förverkliga sin dröm, att skapa ett företag, både för att utmana sig själv och för att driva ett genuint hållbart projekt, både ekonomiskt och ekologiskt!
August Eriksson har studerat Industridesign på IKDC i Lund. Han kommer från Göteborg men spenderade somrarna i Mollösund på Orust. Där föddes intresset för havet och fisket som yrke. Något yrkesfiske blev det aldrig men att skapa något för att bidra till branschens utveckling och komma med nya, innovativa idéer har alltid varit ett mål.
tycker inte att det har stört hans andra sysslor. Göran fiskar främst burkräfta och hinner med att kolla till och utföra mindre underhåll när han är på väg tillbaka från fisket.
Vad gör ni med tången sen?
– Vi stabiliserar tången och hittar en marknad för den. Stabiliseringen görs antingen genom att den torkas eller blancheras och sedan fryses in. Sen är den redo att gå ut på marknaden. Detta är ett stort moment i kedjan och ett som kräver stora insatser om varje odlare hade behövt göra detta på egen hand. Tanken med KOASTAL är att de småskaliga odlarna slipper det steget då vi garanterat våra odlare ett återköp på 100% skörden. När flera bönder går samman så ökar volymen vilket ger större säljkraft, möjlighet att förhandla bättre priser och vi kan nå ut till fler köpare.
Finns det några krav på fiskaren eller fiskebåten och hur mycket tid behöver fiskaren lägga ner?
– Vi ser att det först och främst är yrkesfiskare med lite mindre båtar som passar bäst. Det finns inget krav på fiskaren eller båten som sådan utan de flesta är ju byggda med bra arbetsytor och är mer än kapabla med den utrustningen som redan finns. En tångodling har ju inte jättemycket plats mellan repen så en mindre båt är fördelaktig, då är risken mindre att man trasslar in sig och eventuellt skadar tången eller utrustningen. Mängden arbete under hela perioden uppskattar vi vara runt 100 timmar med två intensivare perioder vid sådd och skörd. Vi på KOASTAL kommer agera som support och all nödvändig utbildning går att få genom oss, allt för att göra driften av odlingen så enkel som möjligt.
Är det under hela året eller en begränsad tid för fiskaren?
– Arbetet med en tångodling sträcker sig från oktober, då man sår sin tång, fram till april då det är dags för skörd. Dessa två är de största och mest tidskrävande arbetsmomenten. Arbetet efter sådd och fram till skörd kräver inte mer än att man åker ut en gång i veckan, eller efter en storm, och kollar till.
Vill man starta en tångodling är det enklast att kontakta oss direkt via vår e-mail, august@koastal.se, eller via vår hemsida Koastal.se. Då kan man få tillgång till mer information och arbetet med att få en egen odling i sitt område kan börja!
Linda FrithiofFött & uppfött i Sverige
Odlat i Sverige
Förädlat i Sverige
Förpackat i Sverige

Kontrollerat i Sverige
Visste du att ursprungsmärkningen Från Sverige även kan användas för svensk sjömat? Kriterierna som gäller hittar du på Företagssidan på frånsverige.se under Regler & avtal. Med märket Från Sverige möter du dina kunders efterfrågan på ursprungsmärkta svenska produkter. Från Sverige-märkningen är välkänd med 86% kännedom och 4 av 5 konsumenter har högt förtroende för märkningen.
Läs mer på frånsverige.se
Med en ny och okänd råvara finns många trösklar att eliminera och resultatet ska vara hållbart, hälsosamt och gott. Som produktutvecklare möter du tufft motstånd och det gäller att vara kreativ och ihärdig. Du tampas bland annat mot fördomar.
– Det är en generationsfråga, för många över 40 sitter det stenhårt att braxen är en skräpfisk, säger Anna Henning Moberg, operativ verksamhetschef på Torsåker gård, Axfoundations centrum för framtidens hållbara livsmedelssystem.
– För oss är det viktigt att alltid ta tillvara på hela fisken, säger Rikard de Man Lapidoth, key account manager på Fisk Idag. Foto: Fisk Idag

Idag äter vi extremt få fiskarter i Sverige. Begreppet Resursfisk står för att ta tillvara på underutnyttjade arter. På Torsåker gård i Upplands Väsby jobbar Anna Henning Moberg och Veronica Öhrvik för Axfoundation, och ett av deras uppdrag är att lyfta braxen från bifångst till matfisk. De utvecklar framtidens mat, och man jobbar med hela värdekedjan; fiskare, förädlare, marknad och forskare – alla är delaktiga.
– Vi ska också bidra till en bättre folkhälsa, så vi vill att produkterna ska vara prismässigt tillgängliga för en bred målgrupp. Vi krokar arm med så många som möjligt, och har inga konkurrenter utan bara potentiella samarbetspartners, säger Anna.
Veronica Öhrvik är teamets näringsexpert och projektledare för flera av Axfoundations sjömatsprojekt. Utöver Anna och Veronica finns här ett operativt innovations- och utvecklingsteam. Råvaran till braxenprojektet kommer som bifångst när man fiskar gös i Mälaren och Vänern. Braxen innehåller många små ben och är svår att filéa. Den är inte vanlig som matfisk i Sverige, men i Finland och Baltikum har man andra traditioner.
– Vi inledde vår research på Åland. Där finns en förädlingsindustri för det här, och vi lärde oss tekniken att tumla fisk för att få ut köttet som en färs. Smaken på braxen påminner om gädda; den är ren och fin, säger Anna.
Ung smakpanel
Teamet har testat allt från queneller, fiskpudding, patéer, biffar och fritters, och de kände starkt att braxen passade för mat till barn. Skolorna har stora problem att hitta god och näringsriktig sjömat som ryms inom deras budget, så det fanns ett behov att fylla.
– Vi bjöd skolbarn på braxenburgare och de gillade det, vilket var väldigt roligt. Om man når en 8-12-åring smakmässigt, det är de som ofta följer med och handlar, och de flesta föräldrar vill att barnen ska äta mer fisk, har man vunnit en konsument. Därför testade vi fish cakes med en modern och het smaksättning med thaikryddor, säger Anna.
Det är bra om produkten ser bekant ut, för vi köper helst mat som vi känner igen. Man vill ha en helsvensk produkt, och för att hålla ner priset blandas färsen ut med åkerböna. Resultatet är ”Fish cake av braxen och böna”.
– Näringsmässigt är det också väldigt bra, eftersom man får in fibrer och andra nyttigheter. Efter att ha utvecklat något som är gott och miljömässigt bra ska man få till produktionen. Man kan tro att vi jobbar med produktutveckling – här blir det en paus med gapskratt – det gör vi, men den gigantiska utmaningen är att få till logistik, infrastruktur och allt sådant. Vi är otroligt affärsdrivna; vi vill att produkten ska sälja även efter att projekt-
pengarna är slut. Bra och hållbar mat ska vara tillgängligt för alla. Men här krävs uthållighet, lanseringstiden behöver vara tillräckligt lång för att konsumenterna ska hinna vänja sig vid innovativa produkter, säger Anna.
– Det gäller att hålla i tillräckligt länge, för Axfoundation påbörjade braxenprojektet 2018 och det rullar inte riktigt på av sig själv än. Det krävs en extrem uthållighet för att få ut en helt ny produkt. Det är väldigt trist när det inte lyckas; det är resursslöseri med pengar, men också med de personer som är involverade. Man tröttnar på att vara med i projekt som inte leder någonstans, säger Veronica.

Det är en fördel att vara bra på produktutveckling, men det är helt andra faktorer som krävs för att gå i mål. Det ska vara miljömässigt, ekonomiskt och socialt hållbart och dessutom gott och näringsriktigt. Att denna fish cake har fått märkningen Från Sverige gör att fler konsumenter hittar den. För övrigt är mer än 70% av all fisk vi konsumerar importerad, enligt Från Sverige.

Produktion på västkusten
Braxenfångsten tar numera vägen om Smögens Fiskauktion och företaget Resursfisk för att bearbetas och bli till fin fiskfärs, en metod som är ny även för dessa erfarna fiskhandlare. Därefter körs färsen några mil söderut till Öckerö, där Fisk Idag har sin produktionsanläggning.
– Vi fokuserar alltid på att ta tillvara på hela fisken, jag tror att det är därför vi blev rätt partner i det här samarbetet, säger Rikard de Man Lapidoth, key account manager på Fisk Idag.

De finhackar blötlagda bönor och blandar upp dem med övriga ingredienser som fisk, grädde och kryddor, därefter formas smeten till biffar. Efter att de blivit stekta fryser man dem direkt, så att de bibehåller textur, konsistens och smak.

– Det var spännande med åkerböna som ingrediens, vi är ett företag som gillar utmaningar. Jag kan erkänna att mina förväntningar inte var så höga, för braxen är en ganska outforskad och svår fisk. Det är en ny, spännande produkt och den har ett bra och viktigt budskap: att vi ska ta tillvara på fler av de sorter vi fiskar upp, och som det finns gott om. Vi har kämpat på från alla håll och kanter, och Axfoundation har varit en bra partner, säger Rikard.
Möjligheterna är många
– Hela 76% av all fisk vi tar upp i Sverige blir foder, det vill vi ändra på. Och sedan tar vi mest filéerna, det finns mycket kött kvar fast det är lite svårt att komma åt det. Om vi använder det kan vi få en jättefin, nyttig och miljösmart produkt, säger Veronica.
Det finns många kundkategorier att försöka nå med innovativa och hållbara produkter; offentliga måltider, hotell, restauranger, delikatessbutiker, livsmedelsbutiker, e-handel och matkasseföretag med flera. Anna berättar att det råder stor brist på sjömat, både i handeln och offentliga måltider, vilket gör att de är
öppna för att titta på alternativa produkter. – Vi är övertygade om att vi har krattat gången för fler produkter av den här typen. Alla svenska producenter skulle tjäna på att se den riktiga konkurrenten: importen. Vi måste samarbeta, och hurra så fort ett svenskt projekt lyckas!
Morgondagens livsmedel finns i havet, med ett överflöd av outnyttjade resurser som innehåller fibrer, mikronäringsämnen och protein.
Evangelia Zioga ägnar sitt doktorandprojekt åt att utforska ett lovande men utmanande alternativ: alger.

– Vi vill skapa något som är både hållbart och hälsosamt.
Fermentering är ett sätt att skapa nya produkter från befintliga råvaror, och kanske kan det hjälpa oss att utnyttja våra hav och deras outnyttjade resurser bättre. Det vill Evangelia Zioga ta reda på. Hon är doktorand, och delar sin tid mellan KTH, Stockholm, och DTU i danska Lyngby. De två universitetens expertis kompletterar varandra, och under en period kommer även Chalmers att vara involverade.
– Sedan tidigare är jag intresserad av både alger och fermentering, så när jag såg detta projekt kändes det som om det var menat för mig. Det är en ”perfect match”. Projektet håller på till våren 2026 och heter Taste-sea, det syftar på ordet tasty, säger Evangelia. Hennes forskning är i första skedet inriktad på brunalgen sockertång, Saccharina latissima Hon tror att alger kan hjälpa oss att uppnå en mer hållbar och näringsriktig livsmedelsförsörjning i framtiden. Att hitta alternativa proteinkällor som kompletterar traditionella råvaror kräver inslag på en ny väg. Det finns en hel del forskning om att fermentera alger, men det mesta gäller framställning av biobränsle, så Evangelia har fått gräva djupt för att hitta litteratur som underlag.
NAMN Evangelia Zioga
ÅLDER 28 år
BOR I Köpenhamn mestadels, men
även Stockholm
FRÅN Trikala, Grekland
YRKE Doktorand på KTH, Stockholm och DTU, Lyngby

– Kunskapen är begränsad och jag har fått översätta artiklar från japanska och kinesiska. I Asien använder man fermentering för att göra soyaliknande såser, men inte så mycket mer. Skandinavisk litteratur behandlar fermentering som en konserveringsmetod, exempelvis inlagd gurka. Vi är ute efter produktutveckling;
hur kan vi nyttja fermentering för att få fram specifika smaker, säger Evangelia.
Alger är en bra proteinkälla och har en fyllig och smakförhöjande arom av umami. Fokus i projektet Taste-sea är algernas smak, men man måste börja med att undersöka om råvaran är säker att konsumera, det spelar ingen roll om maten är god om inte livsmedelssäkerheten finns där.
Inte bara sushi
Idag är torkning den vanligaste konserveringsmetoden, och torkade alger används mest i sushi, bröd och smakförstärkande flakes, men det ger ingen hög andelsprocent i en måltid. I Europa är vi inte så vana vid smaken av alger, och vi vet oftast inte vad vi ska göra med dem. Evangelia tror att det är möjligt att få fram en billigare produkt med bättre potential genom jäsning.
– Tänk dig att man gör en burgare och byter ut 20% av köttmängden till fermenterade alger, det kan tyckas vara en liten mängd, men det blir mycket i stor produktion. Alger har mer fibrer och vissa näringsämnen som inte
”– Tänk dig att man gör en burgare och byter ut 20% av köttmängden till fermenterade alger – det kan tyckas vara en liten mängd, men det blir mycket i stor produktion”
finns i kött, så en burgare med alger i blir extra nyttig. Produkten blir dessutom mer hållbart framställd än en vanlig burgare. Fermenterade alger ser också ut att passa som ingrediens i korv och paté.

Evangelia kommer att forska på hur den optimala blandningen ser ut, och testa produkterna i smakpaneler framöver. Hon och kollegorna har också planer på att samarbeta med bland annat IKEA.
– Konsumtionen av alger är redan mycket låg och produkterna på marknaden är begränsa de, så jag väntar mig både skepsis och rädsla när den dagen kommer att vi kan erbjuda smakprov av nya produkter. Texturen är en utmaning, eftersom fermenterade alger blir lite slemmiga, vilket inte är så lockande.
Hållbar näring för alla
– Just nu laborerar jag med olika mikroorganismer för att fermentera sockertång. Det finns en stor samling jäststammar att testa med på DTU, och några ser riktigt lovande ut. Eventuellt utökar vi och tittar på andra sorters alger senare. De är väldigt olika, både i innehåll och i resultat av fermentering, säger Evangelia.
Man vet att alger är oerhört näringsrika, men det är ännu inte bekräftat att våra matsmältningssystem kan ta upp dessa näringsämnen. Evangelia drivs av hypotesen att jäsning kan vara nyckeln till smakförbättring, hållbarhet och möjlighet för våra kroppar att tillgodogöra sig algernas näringsinnehåll.
– Framtidens livsmedelsförsörjning kommer att vara beroende av att vi gradvis ersätter kött med andra proteinkällor. Förhoppningsvis kan alger bidra till att föda en växande världsbefolkning och
säkerställa hållbar näring för alla. De skandinaviska länderna samarbetar i frågor som detta, vilket är väldigt bra eftersom vi står inför liknande förutsättningar, säger Evangelia.
Den råvara hon jobbar med är sockertång som är skördad på den svenska västkusten. Leverantör
är Nordic SeaFarm och de är förstås också intresserade av att se vilka möjligheter och användningsområden som finns. Alger har högt vatteninnehåll och det är viktigt att man tar hand om den omedelbart, oavsett om den ska torkas, frysas, fermenteras eller användas
Vår framtida mat
Vad är det som gör att nya råvaror realistiskt sett kan bli en del av vår kost? Vi måste inse att konsumenterna har sista ordet. De vill ha hållbart framställd, säker, näringsriktig och god mat. Råvaran finns, men vi behöver vidga våra vyer och matcha marknaden. Haven kryllar av liv och det är dags att vi börjar äta mer av denna naturresurs genom att bredda vår kost. Fermenterade alger kan vara lösningen för en ny sorts livsmedelsframtid och ett sätt att få i oss hälsosamma näringsämnen från havet.
– Kanske kan fermenterade alger bli en del av vår framtida mat. När alger ersätter kött, eller en del av köttet, ger det slutprodukten ett mindre fotavtryck. Nästa steg för forskningen är att utveckla nya produkter, möjligheterna är oändliga.
Katarina SchlägerNu för tiden finns inga lugna perioder på SPF PO. Förhandlingarna avlöser varandra och nu för tiden pågår förhandlingarna i princip året runt. Vi är mitt emellan skarpsillsfisket i Östersjön och fisket efter tobisen. Tobiskvoterna för i år blev bra och ytterligare kvoter byter vi till oss av Danmark för blåvitling. De danska fartygen är större och därför lämpligare för blåvitling.
För oss på SPF PO går tankarna kring fiskets framtid då vindkraftsparker hotar att ta upp viktiga platser för fisket. Bara utmed Bohuskusten planeras fyra vindkraftsparker. Planerna är oroande inte bara för oss utan hela det svenska fisket. Det har länge känts som att motståndet för utbyggnad av vindkraften till havs varit litet. Men nu verkar allt fler grupper i samhället vakna och påtala de stora negativa konsekvenser det kommer innebära. Rimligen bör försiktighetsprincipen även gälla för vindkraftsutbyggnad.
För övrigt jobbar vi på kansliet mycket med vår nybildade stiftelse, Insamlingsstiftelsen Swedish Pelagic Foundation. I stiftelsen har vi påbörjat ett flertal projekt för att öka möjligheterna till mer landningar och beredning av fisk i Sverige. Vi kommer givetvis jobba med många andra frågor inom stiftelsen såsom till exempel dioxinproblematiken, marknadsföring, produktutveckling. Vår nya hemsida för stiftelsen kommer vara klar i början på maj. Vi önskar oss givetvis samarbetspartners så kontakta oss gärna.

Nu efter all god sill under påskhelgen blickar vi framåt och laddar om för midsommarsillen!
Hälsningar Anton, Annelie och Malin
Annelie Rosell, Anton Paulrud och Malin Skog
Swedish Pelagic Federation PO, SPF PO

Sill är vår historia, samtid
Det händer stora saker vid sillkajen i Ellös! Kanhända vi får se en nod för marina livsmedelsnäringar här inom en snar framtid. Ett initiativ som bottnar i bland annat centrumbildningen Blå mat och en gammal vision under benämningen SILLicon Valley har börjat ta form och intressanta samarbeten etableras under det mer korrekta namnet ”Restresursfabriken”
Det startar med sillfabriken i Ellös I hamnen i Ellös ute på Orust ligger Sveriges enda storskaliga sillfabrik. Här har man tagit emot sill sedan 1991, då under namnet Paul Mattsson AB. Sedan 2015 har fabriken drivits av Västkustfisk SVC AB som huvudägare under namnet Sweden Pelagic. Verksamhetens produktionsvolymer bestäms i hög utsträckning av de svenska sillkvoternas storlek. Under senare år har den varierat mellan ca 6000 ton till 12 000 ton sill per år. Fabriken har dock miljötillstånd för att ta emot så mycket som 25 000 ton sill per år. Sweden Pelagic har en kapacitet att bereda upp till 20 ton per timma och detta sker i ett obrutet flöde. I ena änden av fabriken pumpas färsk sill in från båten och i den andra änden kommer färdigmarinerade sill på tunna ut för lagring i företages bergrum, som rymmer drygt 20 000 tunnor.
Ojämnheten i landningsvolym och ett fiske som är koncentrerat till hösten, gör att fabriken har utmaningar med personalbrist under några månader och därefter en överkapacitet i personal. De har under flera år försökt komma till rätta med detta genom att hitta alternativa arbeten för personalen i de befintliga lokalerna. Fabriken har också stora ytor som inte utnyttjas. Det, i kombination med ett antal intressanta nystartade affärsidéer som just saknade dessa resurser såg Martin Kuhlin, VD på Sweden Pelagic som ett intressant case. Visionerna kring ”Restresursfabriken” föddes.


Om vi backar bandet lite så startade det med ett projekt som fabriken hade tillsammans med Chalmers och Ingrid Undeland.


– Ingrid har sedan många år tillbaka sett ett värde i att ta tillvara på mer av den svenska fiskresursen, utöver filéerna, och tittat lite extra på köttet som sitter på sillens ryggben. Vi har hjälpt till med detta, men det var först 2021 som vi tog tag i Ingrids idéer på ett kommer-
siellt plan och började utveckla metoden för att skapa ett bra livsmedel av köttet från ryggbenen, berättar Martin.
I dag har Sweden Pelagic och Chalmers kommit långt i arbetet med att utveckla en process där man på ett livsmedelssäkert sätt utvinner det fina sillköttet som sitter kvar innerst på ryggbenet efter det att sillen fileats.
– Från det att sillen kommer in i fabriken tar det ungefär 30 minuter till att man har färdig filé och färdig färs. Sillens huvud och stjärt kapas i ett första steg innan sillen fileas och resterande sillkött separeras från ryggben i en kött-ben-separator.
Av 10 kilo sill får man 2 kilo ryggben och av dessa får man ut 80% färs. Det gör att man per kilo kan utnyttja 16% mer av fisken.
– Målet är att under 2023 producera minst 500 ton färs, avslutar Martin.
Antioxidantrikt bad hindrar oxidation
– Det svåra med sill är att den härsknar så fort och att förlänga hållbarheten har varit en utmaning vi länge forskat på, säger Ingrid Undeland, professor i livsmedelsvetenskap på Chalmers.
– Länge trodde man att det var de höga halterna fleromättat fettet i sillen som gjorde att den är så känslig för härskning. Nu vet vi att de ämnen som omger fettet har större inverkan. Sillens kött innehåller till exempel mycket blod och därmed det röda
färgämnet hemoglobin vilket kraftigt påskyndar oxidation av fettet. Härmed uppstår ”fiskig” och ”metallisk” lukt och smak, samtidigt som färgen går från rosa till gråbrun, förklarar Ingrid. Genom den forskning som Ingrid Undelands forskargrupp bedrivit har de tagit fram ett antioxidantrikt bad som hindrar oxidationen och förlänger hållbarheten.
– Doppet gör att färsen behåller sin fina rosa färg och sin eleganta smak av hav, båda vilka skapar mängder av användningsmöjligheter, framför allt inom storkök, säger Ingrid.
Katalysator till idéerna kring Restresursfabriken
Parallellt med sillfärsprojektet på Sweden Pelagic har man också samarbetat med ett annat företag, Pelagic Seafood. Pelagic Seafood, som bland annat fanns med i nummer 4 2021, har utvecklat och producerat en ”Bohusburgare” av sillfärs. Samarbetet med Sweden Pelagic har legat i att förlägga och utveckla produktionen av sillfärsbiffar i lokalerna i Ellös.

Detta har lett till att nya idéer fötts och nya samarbeten inletts, bland annat med musselentusiasten Janne Bark och sjöpungsodlarna Marine Taste.


– Det var Lillemor Lindberg på Innovatum som förde oss samman med Musselfabriken och Marine Taste. Hon tyckte att vi ju gjorde samma sak men av olika råvaror. ”Kan inte ni samarbeta” sa hon, berättar Martin.

– Janne Bark på Musselfabriken nappade till hundra procent och har många idéer och tankar om vad man skulle kunna göra tillsammans, och vi har kommit riktigt långt i våra planer. Men vi har också inlett samarbete med Kobb (f.d. Bohus Seaculture) som odlar och producerar livsmedel av tång, säger Martin.
Visionen, säger Martin, är att inom några år ha skapat en nod för marina livsmedelsnäringar i Ellös, där ett 10-tal företag gemensamt nyttjar ett unikt läge och tillgång till logistik, personal, marina råvaror, effektiv teknisk utrustning i pilot – och fullskala, samt inte minst ett enormt nätverk av kompetenta människor som vill samma sak. Restresursfabrikens ”mission” är att på ett effektivt och lönsamt sätt ta tillvara underutnyttjade marina resurser, bifångster och restströmmar och göra dem till nyttiga, goda och hållbara livsmedel.
Kostnadseffektiv produktion med mål att utvinna 100% av råvaran
Janne Bark som under många år drivit och utvecklat Musselbaren i Ljungskile och Smögen, brinner för den fantastiska råvara som blå-



musslan är och vill skapa fler och nya sätt att äta mussla på.
– Det är ett lika unikt samarbete och nätverk som en unik möjlighet att på riktigt skala upp sin produktion till en kommersiell, professionell produktion med stor kapacitet, säger Janne.
I och med att vi kan samnyttja en fullskalig fabrik med alla delar i beredningskedjan så kan vi på ett kostnadseffektivt sätt ta hand om råvarans hela potential även om volymerna inte är enorma med tusentals ton till en början. Vi kan dessutom samnyttja både kapacitet, kompetens, maskiner och viktiga funktioner såsom kvalité, lager och logistik, förklarar han.
Det är stora utrymmen i sillfabriken som är tänkta till den nya produktionsanläggningen och genom att dela på utrustningen blir det billigare för varje företag. Ytan är ca 500 kvm och just nu har man satt i gång arbetet med att göra i ordning lokalerna. Tanken är att få till en steklinje och möjligheter att portionera, packa och frysa.
Utöver att samsas i lokalen och dela utrustning berättar Martin att det också finns tankar om att skapa produkter som innehåller flera av de olika råvarorna.
Både han och Janne ser också en möjlighet i att kunna samarbeta kring marknadsföring och försäljning.
Målet är att utvinna 100% av råvaran Janne berättar att de vill bygga en ”storskalig” produktionslina där de kan förädla blåmusslor och ta hand om musslans fulla potential. Målet är att utvinna 100% av råvaran men också att kunna leverera sina produkter i stor volym med en kostnadseffektiv produktion för att förse marknadens alla led med musslor i olika former och som kan fungera till nästan all vardagsmat.
När vi frågar Janne om när han tror att vi kommer att se detta i skolor, storkök och butik svarar han.
– Jag sticker ut hakan och säger definitivt under 2023 och på ett rikstäckande plan, 2024. Vi är delvis redan där om än lokalt och i väldigt liten skala medan vi väntar på att kunna gå i full produktion. Men i och med att vi har arbetat målmedvetet med produktutveckling och paketering i många år, inte minst genom vårt samarbete med våra egna restauranger Musselbaren i Ljungskile, på Smögen och våra matvagnar där vi kunnat genomföra workshops och provat olika smaker, format, konsistenser och användningsområden. Så vi tror och hoppas att marknaden är redo på bred front. Vi kommer erbjuda flera olika produkter i olika förpackningar och storlekar för musselkött, färs, bullar, burgare och fond.
Mycket behöver bli rätt för att fisken ska hållas färsk hela vägen från hav till bord. Speciellt viktig är en förpackning som håller kyla. EcoFishBox™ är en klimatvänlig fiskförpackning för alla typer av fisk och skaldjur. Den är till största del tillverkad av förnybart råmaterial. Den tar lite plats, är enkel att hantera och att återvinna vilket bidrar till minskad klimatpåverkan, i hela leveranskedjan.

Läs mer om EcoFishBox: www.storaenso.com/sv/ecofishbox

Livsmedel och livsmedelsproduktion har efter de senaste tre årens omskakande händelser, pandemi och krig i Europa, hamnat i ett helt nytt fokus. Regeringen ser över Sveriges livsmedelsberedskap och matpriserna stiger kraftigt i takt med bland annat ökade priser på energi och bränsle. Inom Blå mat vill vi göra vårt yttersta för att möta dessa utmaningar från ett sjömatsperspektiv. Den absolut lägst hängande frukten för att öka vår inhemska produktion av prisvärda sjömatsprodukter är att förädla den blå biomassa som idag lämnar livsmedelskedjan och landet, för foderproduktion. För att kartlägga vilka volymer detta faktiskt rör sig om, samt möjlig potential, deltog Blå mats representanter från Chalmers nyligen i ett regeringsuppdrag vilket offentliggjordes 30 mars1.
I korthet fann vi att det genereras ca 26 000 ton restråvara från svensk filétillverkning och att drygt 100 000 ton liten pelagisk fisk landas utomlands för foderproduktion. Dessa strömmar uppskattas innehålla ca 223 miljarder kcal (!), 20 000 ton högvärdigt protein och 13 000 ton omega-3-rikt fett. Med fler djuphamnar och alternativ processteknik, som inte bara lutar sig på att vi äter filé-delen, kan denna biomassa generera nästan 600 miljoner möjliga måltider/år, dvs ca 1 måltid/vecka för hela Sveriges befolkning. Så den stora frågan är nu, hur skördar vi denna frukt?
I den enklaste av världar hade vi snabbt anammat konsumtionsmönster från till exempel Nord-Norge, södra Europa och Asien där hel liten fisk och alternativa styckningsdetaljer konserveras, tillreds och äts som de är. Detta tycks dock inte troligt, vägt mot den massiva bekvämlighetstrend som råder. Vad vi akut behöver är i stället teknik för industriell produktion av billiga och säkra blå färser och proteiningredienser från råvaror som ryggar, huvuden och hel liten fisk, de senare i vissa fall med förhöjda halter av dioxin/PCB. Naturligtvis krävs också kunskap om, och information till, konsumenten om en ny generation sjömat. Denna kommer nämligen se annorlunda ut än de vita och rosa filéerna vi är vana vid; men ibland med ännu högre näringsprofil och lägre klimatavtryck än dessa.
Inom Blå mat arbetar vi hårt med såväl processutveckling, konsumentattitydanalyser och kunskapshöjande åtgärder. Men vi behöver stöd av sjömatsindustrin för industriell implementering av ny teknik, produktutveckling och marknadskampanjer. Här kan vi inspireras och kroka arm med den gröna revolutionen där nya färser, bollar och burgare exploderar i kyl-/frysdiskarna och där två stora anläggningar nu byggs för proteinextraktion från baljväxter; en i Bjuv2 och en i Lidköping3. Var lägger vi de nya blå proteinproduktionsanläggningarna? Fantastiska embryon har fötts via till exempel Resursfisk (se sid …), Restresursfabriken (se sid …) och GastroSea, det senare där färser från mussla, sjöpung och sillryggben nu samproduceras för att dela infrastruktur. Fler exempel behövs, och precis som läkemedelsindustrin behöver sjömatsindustrin nya blockbusters som kompletterar de dragspelsförpackade frysta laxfiléportionerna. Är det den nya blå falukorven som krävs, eller något helt annat? Låt oss med gemensamma krafter svara på denna fråga och realisera Svensk Sjömat 2.0 från råvaror vi gradvis valt bort, men som tveklöst nu måste plockas in igen för att möta omvärlden.
Ingrid Undeland, Professor i Livsmedelsvetenskap, Chalmers
Referenser:
Vägen framåt mot mer livsmedel av svenskfångad sill och skarpsill Kapacitet i landning och beredning av fisk i Sverige ra23_8v2.pdf (jordbruksverket.se). Sveriges första proteinfabrik invigd i Bjuv – P4 Malmöhus | Sveriges Radio Lantmännen bygger proteinfabrik i Lidköping för en miljard | ATL
Ingrid Undeland, professor i Livsmedelsvetenskap, Chalmers och John Axelsson, doktorand Chalmers.

För mer information: info@havetsskafferi.se
Havets Skafferi, Fiskhamnen, Göteborg Tel. 031-24 10 50
Truckgatan 26, 442 40 Kungälv, Fax. 0303-24 30 75, Tel: 0303-24 30 65 www.lewrens.se
Vi levererar sillinläggningar, röror, burgare, patéer, såser & stekt sill.
Det är inte ovanligt att bohuslänska kustfiskare har en bisyssla vid sidan av fisket, vilket känns som en extra passande beskrivning av Magnus Håkanssons liv. Han har uppemot en miljon bin hemma på gården, en lisa för själen som han själv uttrycker det.
En vit skåpbil med en stor räka på lacken svänger in framför båthamnen i Grebbestad. Det är gott om plats att parkera så här års. Magnus kliver leende ut och räcker fram näven. Vid bryggan intill ligger två av de tre båtar som han har tillsammans med sin kompanjon Eiwe Isacsson. Trålaren SD 43 Helgoland på 35 bruttoton, som främst används för kräftfiske och den gröna räktrålaren SD 62 Theres på 75 bruttoton, en av de 60-tal båtar som är registrerade för
räkfiske längs de svenska kusterna (varav ungefär hälften bedöms vara räkfiskare på heltid).
Räkbeståndet har ökat men kostnaderna skenar Efter en lång fiskarvecka till havs är Magnus på landbacken idag, en av få hemmadagar senaste tiden. Våren är ju en intensiv tid för räkfiskare.

Sommaren är en intensiv period för biodlare. Här jobbar Magnus Håkansson med sina honungsbin på sin gård som ligger mellan Grebbestad och Fjällbacka. Foto: Viktoria Kellgren

– När det gäller räkan har det varit gynnsam ”udavind” med bra fångst. Kräftan har dykt, som det brukar i norra Skagerrak så här års, speciellt vid stökigt väder, men den väntas komma upp igen under nattfisket i början på maj. Men vädermässigt har det varit hårt i vinter, med kyla och starka vindar. Tillsammans med de stora kostnadsökningar som vår bransch genomgått senaste åren måste vi gå ut varenda dag det finns en praktisk möjlighet, säger Magnus.
just nu är ganska mycket i motvind.
Rastlösheten landar bra på sjön
Magnus hamnar trots sina 50 år under yrkesgruppens medelålder som nu ligger över 55 år. En siffra som visar på problem med nyrekryteringen. Men Magnus är fortfarande hungrig på yrket trots att han har jobbat som fiskare i 35 år.
– Tror det beror på att man aldrig blir fullärd i fiskeriyrket. Varje dag tar man upp trålen och snappar alltid upp något nytt som man kan lära av från gårdagen.
Han säger att han är född rastlös (vilket fiskaryrket har klarat av) och att han inte trivdes så bra i skolan, så det fick räcka med ett år på gymnasiet.
Det är en frid att vara på havet, att leva med naturen, säger Magnus Håkansson, fiskare på SD 62 Theres. Foto: Nenne Jacobson Granath
Kvoten för nordhavsräka i Skagerrak och Kattegatt följer den förvaltningsstrategi som EU och Norge har tillämpat sedan 2019. En preliminär kvot är fastställd för första halvåret 2023 och innebär en ökning med 51 procent på årsbasis, jämfört med föregående år. Det finns helt enkelt så mycket räka att det går att fiska mer utan risk för utfiskning. I en kontakt med Göteborgs fiskauktion får vi veta att det hittills i år, fram till sista mars, landade 345 ton räkor vilket är drygt 30 procent mer än föregående år. Men trots dessa goda nyheter tycker Magnus att läget är ansträngt eftersom allt som ska hanteras runt en fiskeriverksamhet i stort sett har fördubblats kostnadsmässigt, samtidigt som räkan inte hängt med när det gäller prisutvecklingen.
– Situationen är sådan att allt material till trålarna, is, salt och lådor har mångdubblats på bara några år, samtidigt som räkorna har tappat i värde och pris. Lägger man sedan till varv, mekaniker, diesel, gasol, bilar, frakter och annat som ska hanteras runt en fiskeverksamhet så har marginalerna sjunkit så lågt det kan i princip. Kräftan har stigit, men det beror ju på att vi kan sälja den på hela världen, till skillnad från räkan och räkor är ju tyvärr sett som lyxmat, så det blir känsligare i sämre tider. Men vi ger aldrig upp och jobbar på även om det
– Jag hoppade av skolan när jag var 16 år och fick en chans att följa med ut på en båt och på den vägen är det. Jag kommer inte från någon fiskarsläkt, men har älskat att fiska sedan jag var liten grabb. Efter skolan sprang jag alltid i väg och metade, det var typ det man gjorde på fritiden.
Vi åker vidare till en lunchrestaurang och fortsätter samtalet över en nylagad kummelfilé. En av få dagar utan räkor för Magnus.
– Ja, men är väl beroende mer eller mindre och längtar alltid efter sältan. När jag är hemma brukar jag koka ihop en fisksoppa med egenfångad fisk och skaldjur, det tröttnar jag aldrig på.
Under sin uppväxt var han mycket hos sin mormor och morfar som bodde på landet och sysslade med biodling. Som 10-åring fick han sitt första bisamhälle och så småningom tog han över gården Skogetorp. Han har fortsatt i sin morfars fotspår och Hagekärrs bigårdar består nu av 15 bisamhällen med två olika arter av Apis mellifera, honungsbin. En gammal nordisk ras, med lite mer ”sting” och en italiensk sort som är en mer from ras. På gården finns också ett 15-tal höns som ger ägg till husbehov.

– Min ståndpunkt är att hela tiden försöka jobba på att bli en bättre människa och att leva så miljövänligt det går. Det känns väldigt fint att syssla med bin som jobbar för den biologiska mångfalden och folk blir ju så glada över att handla lokalt producerad honung. Det ger mig energi!
Magnus berättar att han kan sitta i timmar och titta på sina små surrande bin och fascineras över deras arbetsmoral. Han menar att de lever i ett perfekt ordnat samhälle, där alla vet precis vad de ska göra
”Jag hoppade av skolan när jag var 16 år och fick en chans att följa med ut på en båt och på den vägen är det. Jag kommer inte från någon fiskarsläkt, men har älskat att fiska sedan jag var liten grabb”
och drar sitt strå till stacken. De sysselsätter sig hela livet och dör i fält.























– Det är en underbar stämning på sommaren. De jobbar på under den ljusa tiden på dygnet, är glada och nöjda och gör inte en fluga förnär. Men man måste handskas med försiktighet och känsla på handen, annars berättar snart mina vänner att jag gör fel och det svider lite varstans kan jag berätta.
Att jobba på sjön och samtidigt ta hand om uppemot en miljon bin under sommaren verkar tufft. Han medger att det vara svårt att få tiden att räcka till, inte minst under sommaren när bina är som mest aktiva, samtidigt som sommarturisterna längtar efter färska skaldjur.
– Då får jag ta hand om dem på natten när jag kommer hem. Men det känns inte betungande, det ger en lugn och ro i själen, på ett annat sätt än fisket som är mer av en jakt, där sinnesron infinner sig först när det ger bra resultat.





Trots ljusglimtar är framtiden oviss










Det mesta runt bina ses som väldigt positivt när de flesta förstår den viktiga roll de spelar i ekosystemet och intresset för att bli biodlare har skjutit i höjden de senare åren. När det gäller fisket är tongångarna inte alltid lika positiva, menar Magnus. Han upplever att man misstänkliggörs i sin yrkesroll och att en ensidig mediapublicering och påhoppen från vissa människor ökar frustrationen.

– Alla tycks vara experter och har synpunkter. Det kan kännas tufft, men jag har försökt att bemöta kritiken och har till exempel tagit med blivande marinbiologer och lärare ut på sjön. Jag upplever ofta att de som var skeptiska innan turen vänder när de ser hur vi jobbar. Sedan 2013 fiskas räkor med artsorterande rist och räkorna är MSC-märkta.










Magnus ser tecken på att flera fiskarter har återhämtat sig i Skagerrak.
– Ja när det gäller rödspätta, kolja och till viss del torsk, där ser jag en ökning som jag inte sett under min yrkestid i fisket. Leken har slagit väl ut och de har kunnat återhämta sig en tid med minskade kvoter.
Men trots ljusglimtarna är Magnus bekymrad för det småskaliga kustfiskets framtid. Det krävs stora miljoninvesteringar för en ung fiskare att kunna starta upp, vilket inte är lätt när man vill gå till banken för att låna. Det har också blivit svårt att få tag i bra besättning. Kanske lockar det inte fiskaryrket på samma sätt som det gjorde förr? Man måste klara att ligga ute flera dygn i sträck och ha en konstant sömnbrist, något som den nya generationen kommer ha svårare att hantera tror Magnus.

– Det är en annan livsstil än när jag var ung, kraven ser annorlun-














da ut idag. Men jag minns själv hur det var när barnen var små och man skulle vara borta hela veckan. Tror jag hade söndagsångest de första 10 åren och det kändes inte bra att lämna familjen. Men det är konstigt hur saker och ting kan vända. Nu när barnen är stora och utflugna är det annorlunda. När jag går ut idag kan jag njuta av lugnet på ett annat sätt. Ute på sjön kan jag inget annat göra än att befinna mig i nuet och fokusera på att överleva och min fångst.
Förra året, när Magnus och hans fästmö Viktoria fyllde jämnt tog han en veckas semester och bilade runt i Småland, bodde på spahotell och njöt av sin första semestervecka sedan han började jobba som fiskare. Det gav mersmak och förhoppningsvis finns det utrymme för en ny ledighet framöver. Vi åker ner till Sjögrens i backen, ett trivsamt café som ligger ett stenkast från hamnen. Här brukar fiskeflottan sitta emellanåt, när det inte går att komma ut. På hyllan står honungsburkarna från Magnus biodling.
– Jag hoppas att politikerna ska bli bättre på att ta tillvara på den fina resurs som finns i havet och den goda mat som man får därav. Och räkorna är mer än bara mat, det är en stark symbol för kustens identitet och sommar i Bohuslän.
En kopp värmande te smakar bra den här lite småkalla vårdagen. Doppar ner en sked med len, söt honung och blickar ut mot havet. Om några månader fylls kajen av sommarturister som ivrigt väntar när Magnus kommer in med nykokta räkor. En bild att längta efter.

Nytt från Scotsman – maskiner för tillverkning av krossad is i EcoXserien. Se hela vår miljövänliga serie av ismaskiner på www.mannrox.se








Projektet Testbädd för storskaligt vattenbruk, med nya metoder och teknologier, är igång. Fisk är förstås aktuellt, men så mycket mer; alger, musslor, ostron, sjögurka, sjöpung och sjöborre med mera. – Världen behöver näringsriktig och bra mat, säger Kristina ”Snuttan” Sundell, professor på Göteborgs universitet.
Målet är att tillgodose framtida behov av näringsriktiga livsmedel och biobaserade material. Projektledare är Sotenäs kommun, och i samarbete med innovativa parter från näringsliv, forskning och teknikutveckling vill man lägga grunden för ett hållbart och cirkulärt vattenbruk med början i en avancerad testbädd.


Kristina ”Snuttan” Sundell, professor i zoofysiologi samt föreståndare för Swemarc och Blå mat, forskar kring utveckling av hållbara vattenbrukssystem. Testbädden ska vara flexibel, med möjlighet att testa både nya tekniker och nya arter. Antingen seriekopplar man tankar med exempelvis musslor, fisk och alger i varsin tank, eller kör på enartsnivå. På så vis kan man utvärdera effekter av olika varianter, samt testa filter och kontrollera vattenkvalitet. Testbädden blir av typen landbaserad RAS – alltså recirkulerande vattenbrukssystem, vilket innebär att man renar och återanvänder odlingsvattnet.
– Att producera djurprotein i vatten är mer klimatsmart och hållbart än att producera det på land. Men landbaserade RAS är tekniktunga och kräver utveckling och möjlighet att testa nya, ännu mer hållbara system. Det kan en sådan här testbädd hjälpa till med, att vara en infrastruktur för att möjliggöra testning, utveckling och demonstration av produktionssystemen. En stor fördel med marina livsmedel är att de har bra näringsmässiga egenskaper för oss människor, säger Snuttan.
Begreppet vattenbruk innefattar all odling av vattenorganismer. Asien ligger i framkant, och Kina står för nära 60% av den globala vattenbruksproduktionen. I vår närhet är det Norge som är det stora vattenbrukslandet. Svenska forskare inom vattenbruk har gott samarbete med såväl Norge som globalt.
– Ett av de viktiga målen är att göra sjömat tillgänglig för många fler. Men RAS-system är en teknik- och energikrävande form av vattenbruk, vilket gör att de livsmedel som produceras kan bli ganska dyra. Med tanke på detta tittar vi också på vilka möjligheter som finns för kostnadseffektiv och energisnål produktion. Det är en utmaning, säger Snuttan.
Förstå arternas naturliga miljö Det centrala i utvecklingen av bättre odlingssystem är att organismerna man odlar ska ha så bra hälsa och välfärd som möjligt. Därefter kommer produktion, som tillväxt och produktkvalitet med mera.
– Vi jobbar mycket med laxfiskar; regnbåge, röding och lax, men också med att få till en diversifiering av vattenbruket. För att komma dit behövs forskning på odlingsprotokoll för arterna, exempelvis havskatt, hummer och sjögurka. Genom att förstå hur odlingsmiljö, foder och andra delar ska vara sammansatta för att arten ska trivas, och förstå alla olika stadier i livscykeln, kan vi se om en ny art kan passa för vattenbruk. Eller inte, säger Snuttan.
Genom att göra en analys av organismernas naturliga biologi och förutsättningar får man en första sortering att utgå ifrån. Olika arter är mer eller mindre lämpade för vattenbruk, till exempel är snabbsimmande fiskar svåra att stänga in och få att trivas på mindre yta. Arter som naturligt trivs i grupp kan ha förutsättningar för att passa i vattenbruk, medan arter som lever mer individuellt oftast inte är lika lämpliga.
– Vi måste tänka efter före, och göra dessa analyser för att inte utsätta djuren för onödigt lidande, säger Snuttan.
Strategiskt placerade anläggningar Vad som passar bäst, odling av fisk i öppna system i vatten eller RAS-system på land,
Foto: Mathias Skarp
beror på i vilken omgivning vattenbruket ska placeras. Snuttan understryker att vi inte ska ställa dessa vattenbruk mot varandra.
– Idag importerar vi cirka 45 tusen ton norsk lax per år. Jag hoppas att vi inom fem år kommer upp i samma volym, fast svenskproducerat, genom produktionsökning både av de mer öppna system vi har idag och genom nya RAS. Med flera halvstora enheter utplacerade i landet kan man minska transporter och leverera färsk sjömat till marknaden.
Katarina SchlägerSundell, verksamhetsledare för Nationellt centrum för marin vattenbruksforskning (Swemarc) vid Göteborgs universitet.

Ett uppskattat kursupplägg
En viktig utgångspunkt i kursen var föreläsningar, diskussioner och gruppövningar med fokus på bland annat olika odlingstekniker och beräkningsmodeller för miljöpåverkan, samt lagstiftning och miljötillsyn.
En kompetenshöjande kurs med fokus på vattenbrukets miljöpåverkan och miljönyttor lockade femton deltagare, från både myndigheter och kommuner. Kursen arrangerades 28-30 mars av vattenbruksexperter från Landsbygdsnätverket, Göteborgs universitet och Sveriges lantbruksuniversitet, SLU.

– I dialog med Länsstyrelser och kommuner har vi förstått att många handläggare, som arbetar med vattenbruksärenden, vill lära sig mer om miljö och vattenbruk för att hantera tillståndsgivningen på ett optimalt sätt, sade Veronica Andrén, samordnare på Landsbygdsnätverkets kansli.

Nya kunskaper ger bättre förståelse När handläggare, som ansvarar för vattenbruksfrågor inom myndigheter och kommuner får möjlighet att uppdatera sina kunskaper, utbyta erfarenheter med varandra och diskutera aktuella frågor, får de också bättre förutsättningar för att både förstå och kunna ställa rätt krav på näringen.
– Det händer ju väldigt mycket inom vattenbruket och vi behöver dels hålla oss uppdaterade, dels få mer kunskap om vilken miljöpåverkan och miljönytta olika typer av vattenbruk har. Det är viktigt att ha med sig detta för att få rätt vattenbruk på rätt plats. Och det var även värdefullt att nätverka med de andra kursdeltagarna kring detta, sade Hanna Sallén Lennerthson, marinbiolog vid Länsstyrelsen i Halland.
– Rätt myndighetsbeslut ökar potentialen för en hållbar produktion av livsmedel från vattenbruk, inflikade Kristina ”Snuttan”
– Jag tyckte att kursen täckte många intressanta delar av vattenbrukets potential och utmaningar. Juridikpassen uppskattade jag speciellt, då de redde ut en del frågetecken. Det var också spännande att få en inblick i hur spridningsmodelleringar görs och vilka användningsområden som finns, sade Maria Hedgärde, länsfiskekonsulent på Länsstyrelsen i Västra Götaland.
– Våra kursdeltagare uppskattade kursupplägget med både teknik, miljönyttor och miljöpåverkan. I samband med att kursdeltagarna anmälde sig fick vi veta att de var specifikt intresserade av juridik och algodling. Och vi anpassade kursen efter deras önskemål, sade Veronica Andrén.
Stort intresse för algodlingar
Men kursarrangörerna insåg också, under kursens gång, att deltagarna ville ha ytterligare fokus på alger. Då det just nu är många företag som ansöker om att starta algodlingar i Västra Götaland.
– Det var flera av deltagarna som var intresserade av att få veta mer om hur en algodling påverkar den omgivande miljön. När handläggare får in förfrågningar från personer, som vill odla alger, behöver de ta ställning till algernas miljöpåverkan, sade Anna Norman Haldén, koordinator vid SLU Aquaculture.
– Men alger har egentligen inte så mycket negativ miljöpåverkan, förutom att algodlingarna kan ta upp stora areal i vattnet och skugga botten under odlingarna. Annars är algodling väldigt mycket en win-win situation i och med att de tar upp lösta närsalter från det omgivande havet, sade Snuttan Sundell.
I och med den positiva responsen på kursen har arrangörerna redan börjat fundera kring framtida kompetenshöjande kurser.
– Vi får nog helt enkelt ordna en kurs med fokus på det extraktiva vattenbruket, där blötdjur och alger ingår. Och rikta kursen mot både näring och myndigheter, då en av våra målsättningar med våra kurser också är att få dessa två målgrupper att mötas, avslutade Snuttan Sundell.

Läs mer om fortbildningskursen på: https://www.nkfv.se/utbildningar/akvakompetens-2-0
Susan Gotensparre
Fiskarnas Pensionskassa Försäkringsförening håller ordinarie föreningsstämma stadgeenliga ärenden

Sitter och tittar ut över åkrarna i ett vårfagert sydvästsmåland och ser arrendatorns jättelika gödseltunna stäva som en silltrålare över grönskande åkrar. För en tid sedan körde man omkring med en eka (dvs fyrhjuling) på samma åkrar för att ta jordprover för att veta hur odling och skörd skall ske på ett optimalt sätt för att kunna mätta världens allt fler hungriga munnar. Effektivt och hållbart.
I min ungdom var det på samma sätt med fiskenäringen. Länets fiskerikonsulenter åkte runt och uppmanade vattenägarna att vara effektiva i nyttjandet av vattnen för att förkovra riket med mat, arbetstillfällen och skatteintäkter. De var, skulle man kunna säga, fiskets gödsel. Dessa konsulenter är tyvärr sedan lång tid borta med några få undantag.
Jordprovernas motsvarighet i stora sjöarna var Fiskeriverkets kontor i Örebro, som hade full koll på bestånden. Numera har man noll koll. Inga nya licenser och inga överlåtelser sker av detta skäl längre. Visserligen har regeringen pekat med hela handen i regleringsbrevet, vars förväntade förbislirning från Hav skall bli spännande att åse. Kanske dags att bilda fiskevårdsområdesföreningar i de stora sjöarna. Bevisat utmärkt som förvaltningsmetod i resten av landet!
Våren har blivit sen. I månadsskiftet mars – april gick det exempelvis fortfarande att köra bil på vissa delar av Mälaren. Detta innebär försening i produktionen. Men sådan är naturen, och naturen vinner alltid!
Under våren kämpar vi med PFAS- undersökningar, som redan nu känns trygga. Låga värden i både fisk och kräfta som det verkar. Vi har klarat kvicksilver och dioxin. Nu ska vi klara PFAS, men vad kommer härnäst?

Vi har också ett engagemang tillsammans med MSC för att se om vi på något sätt skall kunna få med mindre sjöar i certifiering utan att det skall kosta en förmögenhet. Och som ni ser i annan artikel i bladet så är vi i full färd med att få i gång produktionen av braxenfärs efter flytten från Stockholm till Smögen. Skiftnycklar yr och proppar ryker, men det börjar funka igen.

Jobbar du i en bransch där livsmedel produceras, förädlas, konsumeras eller återbrukas? Letar du inspiration, vill vidga ditt nätverk och göra nya, goda affärer? Då ska du ställa ut på Elmia Matbruk.
När ni läser detta så har jag lämnat posten som vd för insjöfiskarena och överlämnat hela ansvaret till vår duktige ombudsman Per. Känns väldigt vemodigt men också skönt att vi för förbundet vidare i trygga händer. Man får givetvis lite glirningar från den evigt unge förbundsjuristen Roland Norlén som fortsätter jobba fast han är ett drygt decennium äldre än den nyblivne pensionären. Men Per, Roland, Mats och Maria ska få lite grand extrahjälp av åldringen på Bolmsö även framöver.






I skrivande stund lyser våren med sin frånvaro. Det är slutet på mars och vi är även i år förvånade över att det inte är grönt, varmt och fågelkvitter än. Förhoppningsvis är våren runt hörnet och när ni läser detta så är grillning, picknick och utomhusaktiviteterna igång.
Mars månad på Systembolaget är fullt av vår- och nyhetslanseringar. Den förste mars är det lansering i både fasta sortimentet och säsongssortimentet. Under resten av mars är det weblansering, tillfälligt sortimentslansering och en lansering för Lokalt & Småskaligt. Alltså mycket på gång och många nya vårnyheter att prova. Systembolaget har tillägg till fasta sortimentet fyra gånger per år och tillfälliga och websortimentstillägg kommer flera gånger per månad. Säsongssortiment lanseras 4 gånger per år, vid påsk, oktoberfest, Beaujolais Noveau- släppet och till jul. Sortimentet är med andra ord levande och ändras kontinuerligt. Är ni intresserade av nya drycker så kan lanseringarna följas på Systembolagets hemsida. Där kan man även boka in sig på deras butiksprovningar.
Så mycket nytt som kom nu i mars som är spännande att prova. Våga testa en ny druva, ett nytt land eller en ny typ av dryck. Varför inte ha två glas med olika drycker till måltiden nästa gång? Kul att jämföra, diskutera och hitta oväntade kombinationer. Brukar ofta vara uppskattat på en middag när vi har gäster hemma. Nedan har ni tips på några av vårens nyheter på Systembolaget. Laga till något av recepten, lägg drycken på kylning. Packa sedan med filten, en varm tröja (vi är ju ändå i Sverige) och ge er ut på en vårpicknick. Det mesta smakar ju ändå bäst när man äter och dricker det ute, något som inte går att förklara, det bara är så. Smaklig spis!

Art.nr. 20053 kostar 15,90 + pant.
En Radler vilket innebär en ljus öl som smaksätts med lemonad. I detta fall citruslemonad. I England heter drycken Shandy och i många andra länder kallas det för Panaché. En frisk och fräsch dryck med lite lägre alkohol, i detta fall 3,6 %. Brödig med smak av citrus, apelsin och örter. Bra sällskapsdryck och gott till sill, räksallad och annan lätt vårpicknicksmat.
1

Art.nr. 1924 kostar 28 kr + pant. Äppelmust med smak av björklöv, äpple, ingefära, kryddor, honung och citrus. En kryddig must som passar jättebra till en asiatisk glasnudelsallad med chili-glaserad lax.
Smith Street Sour Olle
Art.nr. 1133 kostar 29,90 + pant.
Ett vetesuröl eller s.k. Berliner Weisse. Ölet är bryggt med ca 25 % vetemalt och blir då syrligt och torrt. Ölet är sedan smaksatt med blåbär, hallon och lingon. Friskt öl som passar bra till rätter med citrustouch, bakpotatis med Skagenröra eller också till getostar och färskostar.
Tunnskuren citronpenslad lax med kräm på blomkål och färskost.
https://sjomatsframjandet. se/recept/tunnskurencitronpenslad-lax-med-krampa-blomkal-och-farskost/


Beskow Brut Nature Havtorn

Art.nr 11987 kostar 22,90 + pant.
Mousserande torrt allkoholfritt som smakar havtorn, mandelmassa och äpple. Dryck som påminner om både en must och en cider, är trevlig både som sällskapsdryck och till en vårprimörsallad med räkor.
Albert
Art.nr. 50209 kostar 269 kr.

Nyhet I beställningssortimentet. Friskt och elegant vin med blommighet och tydlig mineralitet. Smak av äpple, citrus, melon och mineral. Härligt vin till naturella skaldjur men även till eleganta fiskrätter.

Halstrad fiskduett med ljummen primösallad och caesardressing.
https://sjomatsframjandet.se/ recept/halstrad-fiskduett-medljummen-primorsallad-ochceasardressing/
Veltliner Kremstal DAC











Art.nr. 3036 kostar 159 kr.
Nyhet i fasta sortimentet. Fruktig och frisk med mycket smak av bl.a. päron, vitpeppar, örter, melon, lime och ananas. Smakrikt vin som passar bra till rätter med mycket smak och karaktär. Gärna med asiatiska inslag. Gör gärna denna marinad till räkor och vit fisk. Grilla sedan och servera med en krispig och kryddig nudelsallad.
Asiatisk marinad.
https://sjomatsframjandet.se/ recept/asiatisk-marinad/ 6

I Göteborgs stads budget som antogs före årsskiftet ingår ett köpstopp för fisk som fiskats med fångstmetoden bottentrålning, men beslutet verkar ha tagits utan att man först inhämtat nödvändiga fakta och konsultation från expertis. Fisken ska även fortsättningsvis vara miljömärkt och MSC-certifierad. Nu har det kontroversiella beslutet hamnat hos experter på MSC för en lösning.
Marine Stewardship Council – MSC, är världens mest trovärdiga och rigorösa miljöcertifiering. MSC:s standarder erkändes på biodiversitetsmötet COP 15 i Montreal i december 2022 som ett trovärdigt sätt att mäta biologisk mångfald i syfte att upprätta och återskapa den.

Bottentrålning som redskap kan absolut behöva förändras i vissa fall, och MSC erbjuder ett konkret verktyg för att driva olika typer av fisken mot ökad hållbarhet, oavsett redskap. MSC-certifierade fisken bedöms individuellt och får också villkor som de ska arbeta med att lösa under den femåriga certifieringperioden, där tar standarden hänsyn till fiskets ekosystempåverkan och att påverkan inte är irreversibel. Det är viktigt att se att alla typer av fiskemetoder kan ha bifångstproblematik eller påverkan på botten som de behöver arbeta med.
Göteborg ska kunna fortsätta servera fisk till sina skolor och äldreboenden, det borde vara självklart för alla som värnar om våra barns hälsa och utveckling.
Karin Pleijel, gruppledare för Miljöpartiet i Göteborg menar att det finns andra hållbara fiskemetoder som bör användas och anser att kommunen skall driva frågan mot ett mer hållbart fiske. Det här har fått bottentrålningens fördelar och nackdelar att hamna i strålkastarljuset.
I MSC:s nya standard version 3.0, som släpptes i oktober 2022 och som börjar gälla 1 maj 2023, ingår nya hårdare och striktare krav för bottentrålade fisken. MSC har under 25 års tid, framgångsrikt kunnat visa hur man driver storskaliga, industriella fisken mot ökad hållbarhet. För oavsett om vi gillar bottentrålning eller inte så är det en pragmatisk verklighet att det är en effektiv metod för att fånga vissa typer av fiskarter. Att globalt förbättra fiskens miljöprestanda är en enorm ansträngning. MSC samarbetar därför aktivt med forskning, fiskeindustri, livsmedelsindustri, dagligvaruhandeln och miljörörelsen för att uppnå detta. Göteborg stads beslut blir knepigt att genomföra i verkligheten men kastar nödvändigt ljus på vad vi äter och hur det hamnat på tallriken. Forskning från Stockholm Resilience Center
och The Blue foods assessment visar att blå mat från havet har en avgörande roll att spela i övergången till en mer klimatsmart och hälsosam diet, speciellt i länder där befolkningen äter mycket rött kött som i vissa länder i globala Nord, eller där befolkningen är undernärd som i globala syd.
Göteborg stads beslut ställer också många viktiga frågor om politiskt beslutsfattande. Bottentrålning ser ut på olika vis i olika ekosystem och i olika delar av världen.
MSC arbetar nu med att ta fram fisken och volymer som Göteborg stad kan upphandla ifrån, och vi finns alltid nära som experter att bjuda in, även innan beslut tas.
Linnéa Engström, Programdirektör MSC Östersjöregionen och Skandinavien.
 Hela denna sida är en annons från MSC.
Hela denna sida är en annons från MSC.
Här presenteras fyra verkliga primörer! Generellt kommer de flesta fiskarter in till kustnära vatten för att leka då vattnet här har gynnsam temperatur och näringshalt för planktontillväxt och blomningen exploderar när vårljuset börjar tränga ned i vattnet.
Sjurygg (stenbit = hane, kvabbso = hona)

Fisken vandrar långa sträckor mellan djupt vatten på vintern och grundare på sommaren. Den leker februari till maj och hanarna blir då rödaktiga på buken och honorna blågröna. Sjuryggen är en bifångst under vårens kustnära fiske. Hanens kött är uppskattat och har en fast textur. Romen används till ”Limfjordskaviar” och är naturligt ljuslila till grårosa i färgen. Den mesta stenbitsrommen kommer från Island och Norge. Den färgas oftast svart eller orange och säljs som ”stenbitsrom” trots att den kommer från honan, kvabbson. I välsorterade fiskdiskar finns ibland möjlighet att köpa ofärgad rom.
Makrill




Makrillen övervintrar på djupt vatten och vandrar mot kusterna på våren för att leka. Fisken är mager på våren och räknas som en primör. Konsumenterna kan följa makrillens vandring genom att lägga märke till fångstområdena, spansk, skotsk eller norsk makrill kommer innan den anländer den svenska kusten. Efter leken tar den till sig näring i stora mängder och blir snabbt fet ut på höstkanten. Då blir den bäst att röka, grava eller salta in.
Bleka, lyrtorsk Blekan lever pelagiskt i den öppna vattenmassan men de största fiskarna finns runt berg- och stenbotten. Det är en god matfisk med låg fetthalt som kan användas som ersättning för torsk, kolja och sej. De största bestånden finns väster om de brittiska öarna och fisken är relativt okänd för den svenska konsumenten. Texturen är något fast och den är en fantastisk råvara till produkter av fiskfärs.
Tång
Under framför allt april månad säljs färsk tång då den äts som primör, framför allt sockertång men också havssallat. Från februari fram till sommaren finns olika arter att skörda vilt, men ryck inte upp plantor utan använd en sax. Då är alla arter extra mjälla, mjuka och fina. Längre fram på våren och in på sommaren börjar tången få påväxt av andra arter som ludna alger, havstulpaner och tångbark. Tången går egentligen att plocka mer eller mindre hela året, men olika arter har olika säsonger. Tången används framför allt som smaksättning och bidrar med djup och lyfter fram de andra smakerna. Den går att fritera, pickla, fermentera, kandera och torka. Använd den som smaksättning i bröd, fröknäcke eller småkakor genom att byta ut en del av mjölet till torkade tångflingor.
Ilona MiglavsDet är inte bara Rysslands anfallskrig mot Ukraina som spökar i dessa svåra tider – till exempel lägger även det norska Stortinget så att säga lök på laxen genom sin planerade grundränteskatt på laxodlingar. Men vår bransch står också under starkt förändringstryck på andra sätt. Dels att vi pratat i åratal om hur andra marknader kommer påverka prisbilden – och nu har det blivit verklighet. Dels att vår svenska konsumtion så starkt domineras av premium-arter som lax, torsk och räka – och nog måste anpassas till ett mer internationellt mönster för att inte sjömat ska vara en sällsynt lyx för ett fåtal konsumenter.
Kort sagt så befinner vi oss i något som påminner om den perfekta stormen, med både strukturella och händelsestyrda förändringar. Enda sättet att komma levandes ut ur den är att utvecklas och tänka nytt både som bransch och politik. Och precis det diskuterades på Sjömatsforum den 30 mars.
Vi fick en samstämmig bild från dagligvaruhandeln, specialisthandeln och Norges Sjömatråd om sjunkande sjömatsförsäljning. Representanter för dagligvaruhandeln målade upp ett särskilt dystert scenario. Man menar att konsumenter väljer billigare alternativ när det gäller kött – till exempel falukorv istället för fläskkött. Men när det kommer till sjömat så väljer man i stället bort hela kategorin. Detta kan få allvarliga konsekvenser för hela näringen. Speciellt som statistik från Norges Sjömatråd visar att i synnerhet yngre grupper i stor utsträckning väljer bort fisk och skaldjur när priset ökar.

Fanns det inga ljuspunkter då? Jodå! Ingrid Undeland, professor på Chalmers och entreprenör inom nya livsmedel pratade engagerat om utvecklingen av nya produkter, som till exempel färs gjord på ryggben från sill. Den kostar som blandfärs och kan beredas som exempelvis kroketter, med god smak och högt näringsvärde. Detta sätt att tänka, alltså att tänka i termer av människa, miljö och ekonomi hyllades också av FinnArne Egeness som är chefsanalytiker för sjömatsektorn på Nordea Markets. Han pratade om triple-bottom-line, vikten av hållbarhet och nödvändigheten att produktutveckla i alla led. Så nu får vi gå hem och fundera på själva knäckfrågan: Vad blir vår falukorv?
Varmt välkomna!
Krishan Kent, ordförande i Fiskbranschens Riksförbund (FR)

Guldhaven pelagiska är en produktionsanläggning i Kalix med 30 års erfarenhet av hållbart fiske. Här produceras produkter av regnbåge, Siklöja, vildlax, braxen och id. Både hel fisk, filé, färs, rom och biffar. De senaste åren har ett stort arbete lagts i utvecklingen av produkter från braxen och id. Vi kontaktar Guldhaven och Teija Aho för att få höra lite om deras arbete med utvecklingen av braxenfärsbiffarna.
Hur startade arbetet med Braxa?
Teija Aho, vd för Guldhaven pelagiska, har en bakgrund inom forskningen och är även vice vd för Sveriges fiskares producentorganisation.

– Jag blev kontaktad av John Nurminenstiftelsen som är en miljöorganisation i Finland berättar Teija. De hade gjort ett liknande projekt i Finland och efter ett möte i Helsingfors startade vi upp projektet 2019. Då gick Race for the Baltic in i vårt projekt. För att ha tydliga regler för fisket och hur fisken skulle fångas på ett miljömässsigt bra sätt skrevs ett kontrakt mellan fisket och Race for the Baltic. Utöver det hade vi en referensgrupp där Havs- och vattenmyndigheten, Länsstyrelsen, Sportfiskarna och SLU satt med.
Hur kommer det sig att det blev just braxen?
– Att det blev just braxen var för att det var en art som var underutnyttjad. Men till skillnad från projektet Resursfisk har vi inte braxen som en bifångst här, utan vi bedriver ett riktat fiske mot braxen, förklarar Teija. Braxen fångas med stora ryssjor eller bottengarn som det heter på ostkustsidan. Här har man arbetat med redskapsutveckling för att minska bifångsten och skapat utflyktshål för arter såsom bland annat abborre och små braxen.
Provsmakningar och samarbeten har lett oss framåt Arbetet med att ta fram braxenfärsen och de färdiga biffarna som man kallar Braxa, har man utvecklat på plats i Guldhavens anläggning i Kalix.
Processen börjar med att man rensar och fjällar fisken. Huvudet tas bort och därefter styckas fisken upp i mer lätthanterliga bitar. Genom att använda en kött-ben-separator får man fram en helt benfri
färs som kan användas antingen som den är eller i produkter såsom fiskbiffar.
– Det har varit en del trial and error, berättar Teija. Vi har också haft en del provsmakningar ute hos våra kunder för att hitta rätt. Dessutom har vi fått hjälp av Frida Ronge att ta fram menyer på hur biffarna skulle kunna användas i kombination med andra råvaror.
– Själva Braxa biffarna består av huvudsakligen braxenfärs men
även en viss del regnbågsfärs för att få en bra fetthalt, vilket efterfrågas i offentliga kök. Biffarna har annars en neutral smak och är milt kryddade med dill, salt och peppar. På så sätt kan köken anpassa den till deras egen verksamhet och sätta sin egen prägel på rätten, förklarar Teija.


I början producerade Guldhaven biffarna själva men nu görs de i Finland som har lång erfarenhet av processen. Biffarna kan man hitta hos de flesta större livsmedelsgrossister men de håller på att lanseras både hos Ica och Coop berättar Teija.
8 ton braxenfärs produceras per år För att få lite uppgifter om produktionen och hur mycket som produceras, pratar vi med Emma Gabrielsson som är hållbarhetschef på Guldhaven.
– Vi rensar ungefär 18 ton braxen, både som vi själva fiskar men också från andra fiskare som vi samarbetar med. Vi får ut ungefär 45% av fisken, så ungefär 8 ton färs. Av det har vi hittills producerat cirka 5-6 ton biffar (vilka har ett innehåll på cirka 60 % braxen), så vi har en del kvar, svarar Emma.
Siklöjan – en god matfisk
Utöver Braxa-biffarna jobbar man även med att försöka få in siklöjan som en produkt. På Guldhaven producerar man löjrom och det är från siklöjan man får den. I fisket efter siklöja får man upp honfiskar så väl som hanfiskar. Både går att använda men hur mycket av honorna man kan använda beror på vilken process man använder när man tömmer dem på rom, förklarar Teija. För att kunna använda fiskköttet behöver man rensa och ta ut rommen för hand. Idag används oftast en metod som är tre gånger så snabb, där man bryter av fisken. Det är effektivt men gör också att köttet tyvärr inte går att använda. Siklöjan är en jättegod matfisk men vi svenskar är ganska enkelspåriga då det kommer till vårt val av fisk och det är inte lätt att få in nya produkter på marknaden säger Teija.
– Helst skulle vi vilja sälja dem huvudkapade. De är jättegoda att fritera hela eller filéa och använda till boquerones, avslutar Teija.
Linda Frithiof

Årets succémässa i branschen, Nordic Seafood Summit repriseras 2024. Denna gång i Göteborg 24-25 januari. Mässan är den första i sitt slag att samla sjömatsbranschens samtliga aktörer.
Nordic Seafood Summit samlar hela värdekedjan, från fiskare och odlare till grossister, förädlingsindustri, handel, restaurang, forskare, beslutsfattare och myndigheter. Mässan bjuder därför på en unikt god möjlighet för näringens alla aktörer att få en bred inblick i branschens förutsättningar, utmaningar och möjligheter.
– Målsättningen är att upprepa den känsla av gemenskap och framåtanda vi hade senast genom att fokusera på lösningar snarare än problem, på framtid snarare än dåtid, och på det som förenar snarare än det som skapar konflikt, säger Susanne Ekstedt, innovationsledare på Innovatum Science Park.
På Eriksberg i januari kommer man kunna ta del av de senaste produkterna, nyheterna och diskussionerna och möta både besökare och branschkollegor.
Vi som står bakom Nordic Seafood Summit
Joakim Petersén, vd Finnvacum

Peter Sjöholm, vd Västkustfisk AB

Pelle Lindquist Omberg, konsult inom sjömat

Susanne Ekstedt, innovationsledare, Innovatum Science Park

Välkommen att kontakta oss! www.nordicseafoodsummit.se
– Det är redan högt tryck på deltagande i mässan och en del uppbokat. Men det är inte försent att anmäla sitt intresse som utställare, sponsor eller för annan samverkan, säger Susanne Ekstedt.
Arrangörernas målsättning är att skapa en plattform för dialog och inspiration kring hur man gemensamt kan möta de utmaningar som finns, och samtidigt skapa bättre förutsättningar både ekonomiskt och hållbarhetsmässigt för branschen som helhet.
– Vi vill vara med och skapa en infrastruktur för skandinavisk sjömatsnäring där vi möjliggör bättre produkter, främjar fler samarbeten samt lyfter branschens utmaningar och möjligheter. En mötesplats så som Nordic Seafood Summit ligger helt i linje med detta arbete, säger Joakim Petersén, vd för Finnvacum.
Mässan sponsras av MSC (Marine Stewardship Council) och ny samarbetspart för i år är Fiskbranschens riksförbund. Se nedan.

Hallå där Krishan Kent, styrelseordförande Fiskbranschens riksförbund! Ni går in som samarbetspart till Nordic Seafood Summit, varför det?
– Sjömatsnäringen i Sverige är viktig ur så många aspekter, från hälsa till livsmedelsförsörjning och viktiga arbetstillfällen i våra kustkommuner. Det är också en viktig del av vår svenska mattradition och kultur, inte minst vid våra högtider. Tyvärr kommer svenskproducerad fisk och skaldjur ofta i skymundan, trots att vår bransch har flera tusen anställda i Sverige och är största arbetsgivare i flera kustkommuner med en omsättning på över 30 miljarder SEK.
Vad betyder mässan för branschen?
– Nordic Seafood Summit ger en möjlighet att inte bara tala om vår näring, utan också smaka på den. Mässan är unik eftersom hela den blå livsmedelskedjan är representerad. Tillsammans har vi möjligheten att öka både kunskap och stoltheten för våra företag och branschen i Sverige och visa på den potential sjömat har på den svenska marknaden. Nordic Seafood Summit skapar också den enda nationella mötesplatsen där vi i branschen, myndigheter och politiker enkelt kan mötas och forma en långsiktigt positiv och hållbar sjömatsbransch.
I januari 2024 arrangeras sjömatsmässan Nordic Seafood Summit i Göteborg, i Eriksbergshallen vid det gamla båtvarvet med fantastisk utsikt över vattnet. Joakim Petersén, vd Finnvacum Peter Sjöholm, vd Västkustfisk AB Pelle Lindquist Omberg, konsult inom sjömat Susanne Ekstedt, innovationsledare, Innovatum Science Park Krishan Kent, styrelseordförande Fiskbranschens riksförbund Hela denna sida är en annons från Nordic Seafood Summit.Glöm inte att nominera din kandidat till Årets Fiskavdelning
2023 arrangeras Dagligvarugalan för femtonde året i rad. Den drivs av tidningen Fri Köpenskap för att uppmärksamma en bransch som ibland tas för given i vardagen. Galan lyfter fram goda exempel på handlare och medarbetare som utvecklar utbud och upplevelse för konsumenten. Den har utvecklats till ett av branschens viktigaste event och numera arrangeras även regionala galor i Götaland och Norrland.
Juryordförande Hans Roos af Hjelmsäter.
Själva tävlingen innehåller inte mindre än 22 kategorier. Den allra viktigaste är förstås (!) Årets Fiskavdelning. Vinnaren ska vara en butik som skapar mervärde med kunskap, inspiration och aktiviteter i hela fiskavdelningen. Alltså både över den manuella disken och i hyllan. Sortiment, miljö och nytänkande är avgörande i juryns bedömning. Juryn, ja. Där ingår både Krishan Kent och Mette Gemzöe från Fiskbranschens Riksförbund, jämte representanter för dagligvaruhandeln och Norges Sjömatråd. Ordförande är Hans Roos af Hjelmsäter från Fri Köpenskap. Han säger så här om galan och juryarbetet:
”I dessa tider med stigande kostnader så blir jag väldigt inspirerad av alla duktiga människor i dagligvaruhandeln. De hjälper kunderna med val av fisk och vilka rätter de kan laga till. Fiskavdelningarna är värda all heder och jag är tacksam över att få vara delaktig i processen att utse Årets Fiskavdelning till Dagligvarugalan 2023. Glöm inte att nominera er butik!”
Nominera din favoritfiskavdelning på dagligvarugalan.se senast den 31 maj. Vinnaren presenteras i Stockholms Stadshus den 16 november.
Peter Linder
Fiskeriförhandlingarna mellan EU och Norge, som påbörjades hösten 2022, var den här gången ovanligt komplicerade och segslitna. Först den 17 mars 2023 var parterna i hamn och undertecknade avtalen. Frånvaron av tillträde till traditionella och viktiga fiskeplatser i norsk zon, framför allt för räkfisket under kvartal 1, har varit kostsamt för västkustfisket. SFPO har noga följt förhandlingarna och spelat en viktig roll. Vi kan konstatera att det helt enkelt inte duger att svenskt fiske stängs ute från traditionella och viktiga fiskeplatser. Nu gäller det att både EU och Norge drar rätt slutsatser inför framtiden och påbörjar förhandlingarna i så god tid i höst att avtalen är på plats till den 1 januari 2024. Det är dock glädjande att kunna konstatera att den svenska torskkvoten i Skagerrak har ökat från 265 t till 433 t. Det är också glädjande att räkfisket nu får ett helt kvotår i stället för ett halvt. När ICES släpper råden för räka inom kort börjar förhandlingarna igen. I februari anordnade SFPO ett frukostseminarium i riksdagen. Seminariet var välbesökt och intresset för fiskefrågorna stort. Fokus låg på systemfrågan. Havs- och vattenmyndigheten hade i januari presenterat sin redovisning av regeringsuppdraget angående faktorer att beakta i system med överlåtbara fiskerättigheter. Myndigheten föreslog regeringen att gå vidare med förslagen till ändringar i lagstiftningen som krävs för att kunna införa överlåtbara fiskerättigheter i det demersala fisket. Behovet av ett enklare och mer transparent regelverk, ökade möjlighet till ett mer lönsamt fiske och större möjligheter till att kunna anpassa fiskemöjligheter efter sitt individuella fiske är anledningar som gör det nödvändigt att få på plats ett system med överlåtbara fiskerättigheter så snabbt som möjligt.
Ett överhängande och latent hot mot det svenska yrkesfisket är den marina vindkraftsindustrins expansionsplaner. Om de planerade vindkraftsparkerna blir verklighet kommer de tillsammans med skyddade områden etc. att leda till en situation med platsbrist för basnäringen yrkesfiske. Utan fiskeplatser kan svenskt yrkesfiske inte fullgöra sitt viktiga uppdrag att förse konsumenter med fisk av högsta kvalité. Vi känner en mycket stor oro inför situationen. Antalet pågående projekt är långt mycket större än vad som rimligen kan tillåtas och att vindkraftparker ska byggas på områden av riksintresse för yrkesfisket förefaller bisarrt. Ingen har vetskap om effekterna av storskalig marin vindkraft över tid och behovet av vetenskapliga analyser är påtagligt.

Vi har synpunkter på hur Havs- och vattenmyndigheten fungerar och har framfört vår kritik direkt till myndigheten. Vi hade i början av mars tillsammans med andra fiskeorganisationer ett samrådsmöte om samråd med myndigheten. Det mötet resulterade i att Havs- och vattenmyndigheten nu inom kort ska återkomma med en analys av mötet och förslag på hur vi ska vidare.
2023 kunde ha börjat bättre; men vi gör allt i vår makt för att saker och ting ska bli bättre för svenskt yrkesfiske.
Peter Ronelöv Olsson Ordförande SFPO
Specialister på kyltransport och distribution av fisk, skaldjur och sjömat i Bohuslän
Från havet!
”Väldigt positivt överraskad!”
”Smakar inte fisk!”
”Jag använder den som köttfärs och ungarna älskar den!”
I ett samarbete med institutionen för biologi och bioteknik vid Chalmers tekniska högskola har vi på Sweden Pelagic tagit fram en MSC certifierad smakneutral marin färs från det svenska pelagiska fiskets sidoströmmar. En produkt, rik på antioxidanter, gjord från de proteinrika delarna av den svenska sillen. Vi är mycket stolta över att äntligen kunna erbjuda svenska konsumenter en prisvärd och helt igenom svensk produkt!


Kontakta oss för offert och information!
Telefon: 0304-548 75
Order: order@swedenpelagic.se




Mail: lars@swedenpelagic.se
Mobil: 072-333 36 53
Färskskalad svensk lakeräka fiskad i Skagerrak
Levereras färsk till vår kvalitetscertifierade produktionsanläggning belägen i Buas fiskeläge, Halland där den kokas, maskinskalas och packeteras.
Kan packas i valfri vikt enligt kunds önskemål.
Kunskap och teknik att ta hand om den känsliga råvaran på bästa sätt!
Förädlad norsk lax av högsta kvalitet
I ett pressmeddelande från Naturvårdsverket meddelar de beslut om licensjakt på gråsäl samt knubbsäl och tillåter skyddsjakt på vikare under 2023 och början av 2024. Skyddsjakten på vikare riktas mot de individer som kan orsaka skada på bland annat fiskeredskap och fångsten i redskapen.
Licensjaktens huvudsyfte är att förekomma och hindra skador orsakade av gråsäl och knubbsäl inom yrkes- och fritidsfisket i Sverige. Totalt får 1 500 gråsälar fällas av den totala Östersjöpopulationen som beräknas vara mellan 49 000 – 61 000 individer.
För andra året tillåter Naturvårdsverket även licensjakt på knubbsäl. Det är 630 knubbsälar som tillåts fällas i den kommande licensjakten på västkusten varav 400 i Västra Götaland, 200 i Halland och 30 i delar av Skåne. De två knubbsälsbestånden i Kattegatt och Skagerrak uppskattas tillsammans vara ca 20 400 individer.
– Populationerna av gråsäl och knubbsäl är livskraftiga och förvaltningsmålet är att de fortsatt ska ha gynnsam bevarandestatus. Däremot orsakar sälarna omfattande skador inom fisket, sälarna tar exempelvis fisk ur fiskenät och förstör fiskeredskap. Genom licensjakt är det lättare att i skadeförebyggande syfte begränsa populationerna, säger Hanna Ek, biträdande enhetschef på viltförvaltningsenheten.

Till skillnad från gråsäl och knubbsäl kan Naturvårdsverket endast fatta beslut om skyddsjakt på vikare. Vikarens population bedöms minska på sikt i och med minskade havsisar som vikaren är beroende av under kutningsperioden. Därför är antalet vikare som tillåts fällas 350 individer av en total population på minst 15 000. Skyddsjakt på vikare behövs för att förhindra de skador som vikaren orsakar och riktas mot skadegörande individer. Det innebär att skyddsjakten bara får bedrivas exempelvis inom 200 meter från fiskredskap eller fredningsområde för fisk där de bedöms kunna orsaka skada.
Licensjakt skiljer sig från skyddsjakt på så sätt att det får bedrivas över större områden utan anslutning till de platser där de orsakar skador för exempelvis yrkesfisket. Skyddsjakt används i första hand för att begränsa lokala, akuta skador och skador från enskilda sälar.
https://www.naturvardsverket.se/om-oss/aktuellt/nyheter-och-pressmeddelanden/2023/april/beslut-om-licensjaktoch-skyddsjakt-pa-sal/

Vi på redaktionen välkomnar tips, åsikter och idéer från er läsare. Hör av er till info@sjomatsframjandet.se

Varje år lanserar Klädesholmen Seafood en nyhet till sillhyllan under namnet Årets Sill. När den femtonde upplagan togs fram var det dags för en klar sillinläggning med smak av Grönt te & Citrus. I år lanserades Årets sill vecka 11, lagom till påsk Men självklart uppmärksammas Årets sill även på Sillens dag den 6 e juni precis som tidigare år.
Förslagen till Årets Sill tas fram av Salt & Sill och dess personal. Efter juryns val kvarstår Klädesholmen Seafood’s arbete med att utveckla en sillinläggning som är anpassad för fabriksproduktion med en längre hållbarhet.
I år var det äntligen östkustens tur att få agera jury. En kylig höstdag fick Munsö/Ekerö Sjöräddningsstation besök av Klädesholmen Seafood och restaurang Salt & Sill som presenterade de utvalda nomineringarna av sillinläggningar. Juryn, som vanligt bestående av mycket engagerade sjöräddare, fick avlägga sin röst på den sill som föll dem bäst i smaken. Som vinnare stod Grönt te & Citrus som får sin friska smak från bland annat citronverbena, citrongräs och grönt te.
En krona per såld sillburk går direkt till Sjöräddningssällskapet och deras arbete för ökad säkerhet till sjöss. Genom sina 74 stationer längs Sveriges långa kust och i de stora sjöarna utgår 2 400 frivilliga sjöräddare har jour dygnet runt, året om.
Vi bygger en plattform för att göra blå biobaserade tekniklösningar mer tillgängliga.
Är du med?
Scanna QR-koden! Eller kontakta: sonja.andren@innovatum.se


– Rapport framtagen av Havs- och vattenmyndigheten
tillsammans med Energimyndigheten
En utbyggnad av stora vindkraftsparker långt ute till havs kommer att inkräkta på andra samhällsintressen och kräver prioriteringar. Yrkesfisket är den näring som har svårast att samexistera med utbyggd vindkraft till havs. Det enligt en rapport som Havs- och vattenmyndigheten tagit fram tillsammans med Energimyndigheten. Bland yrkesfiskare är oron stor för hur planerna kommer påverka deras framtid.
info@sjomatsframjandet.se
4 maj
Matdagen 2023
Livsmedelsföretagen Stockholm
https://www.matdagen.se
5 maj
Guidad tur på Göteborgs fiskauktion
https://sverigesradio.se/artikel/ yrkesfiskarna-om-vindkraftverk-till-havs-blir-dodsstoten-for-fisket
https://sverigesradio.se/artikel/ ny-rapport-vindkraften-blir-inte-smartfri-varst-for-yrkesfiskarna
https://sverigesradio.se/artikel/ reportern-forklarar-de-omfattande-vindkraftsplanerna-till-havs-och-hur-de-kan-inkrakta-pa-fisket
Nu samlar Axfoundation och Sveriges lantbruksuniversitet (SLU) praktiker och forskare från Boden till Öland för att utveckla framtidens foder för matfågel, värphöns, fisk och gris. Förhoppningen är att ersätta ingredienser som importerad soja och vildfångad fisk i konventionellt foder, med mer resurseffektiva och cirkulära råvaror som har betydligt lägre miljö- och klimatpåverkan. Just nu undersöks bland annat insekter uppfödda på matavfall, blåmusslor som renar Östersjön och mykoprotein som matats med restströmmar från skogsindustrin.
– Vi har redan bevisat att det går att föda upp svensk regnbågslax på foder gjort av bland annat insekter, ett foder med upp till 70% lägre koldioxidutsläpp än vanliga foder på marknaden. Nu skalar vi upp rejält med ännu fler ingredienser och satsar på framtidens foder för produktion av fågel, ägg, fisk och fläsk. På sikt är ambitionen att den här typen av foder med resurssnåla och cirkulära ingredienser ska kunna användas i stället för dagens konventionella foder, säger Christian Sjöland, Projektledare inom Framtidens mat på Axfoundation.
Livsmedelssektorn står för cirka 1/3 av världens växthusgasutsläpp och animaliska livsmedel har störst påverkan på miljön och klimatet. Fodret i sin tur står för störst andel utsläpp, det utgör 50
85% av klimatutsläppen från fisk, gris, matfågel och ägg i Sverige. Idag består konventionellt fiskfoder på marknaden ofta av importerad vildfångad fisk vilket ökar pressen på världshaven.
Projektet Framtidens Foder för Fågel, Fisk och Fläsk samlar forskare och aktörer från hela livsmedelskedjan. På mindre än två år är ambitionen att sätta upp en pilotproduktion av foder och testa försäljning av matfågel, gris, fisk samt ägg från värphöna uppfödda på foder med lägre klimatpåverkan och med ingredienser som gynnar den biologiska mångfalden.
Foderingredienser som kommer att testas är bland annat mykoprotein från svamp som matats med restströmmar från skogsindustrin, blåmussla från Östersjön som renat vattnet från kväve och fosfor och på så sätt bidrar till minskad övergödning, restprodukten från framställning av koncentrat från svensk åkerböna vilket har låg attraktionskraft som livsmedel, samt insekter som amerikansk vapenfluga och mjölmask uppfödda på matsvinn från livsmedelsindustrin.
https://www.mynewsdesk.com/se/axfoundation/pressreleases/storsatsning-paa-framtidensfoder-insekter-och-fodermusslor-ska-ersaetta-vildfaangad-fisk-och-soja-3246354
https://sjomatsframjandet.se/nyheter/ folj-med-pa-en-guidad-tur-pa-goteborgsfiskauktion
23 maj Oslo
Skalldyrkonferansen 2023
https://seafood.no/aktuelt/konferanser-og-seminarer/skalldyrkonferansen-2023/

24-25 maj
EMD European Maritime Day Brest, Frankrike
https://maritime-day.ec.europa.eu/index_en
31 maj – 1 juni


Nordic Future Food & Food Tech Stockholm
https://nordicfuturefood.se
6 juni
Sillens dag, Klädesholmen
https://kladesholmen.se/sillens-dag/

5 - 13 augusti
Västerhavsveckan
https://www.vgregion.se/ov/vasterhavsveckan/
14 september
Scanpack Pop-up, Svenska
Mässan, Göteborg
https://scanpack.se/pop-up/
Redan 1594 var Klädesholmen

utanför Tjörn ett välkänt fiskeläge. Här har våra förfäder saltat sill i generation efter generation och utvecklat sillen till en inlagd
delikatess. Här har vi kvarvarande familjeföretag förenat oss under varumärket Klädesholmen för att bevara och förnya den svenska silltraditionen.






Besök gärna vår hemsida
www.kladesholmen.se
KLÄDESHOLMEN SEAFOOD AB